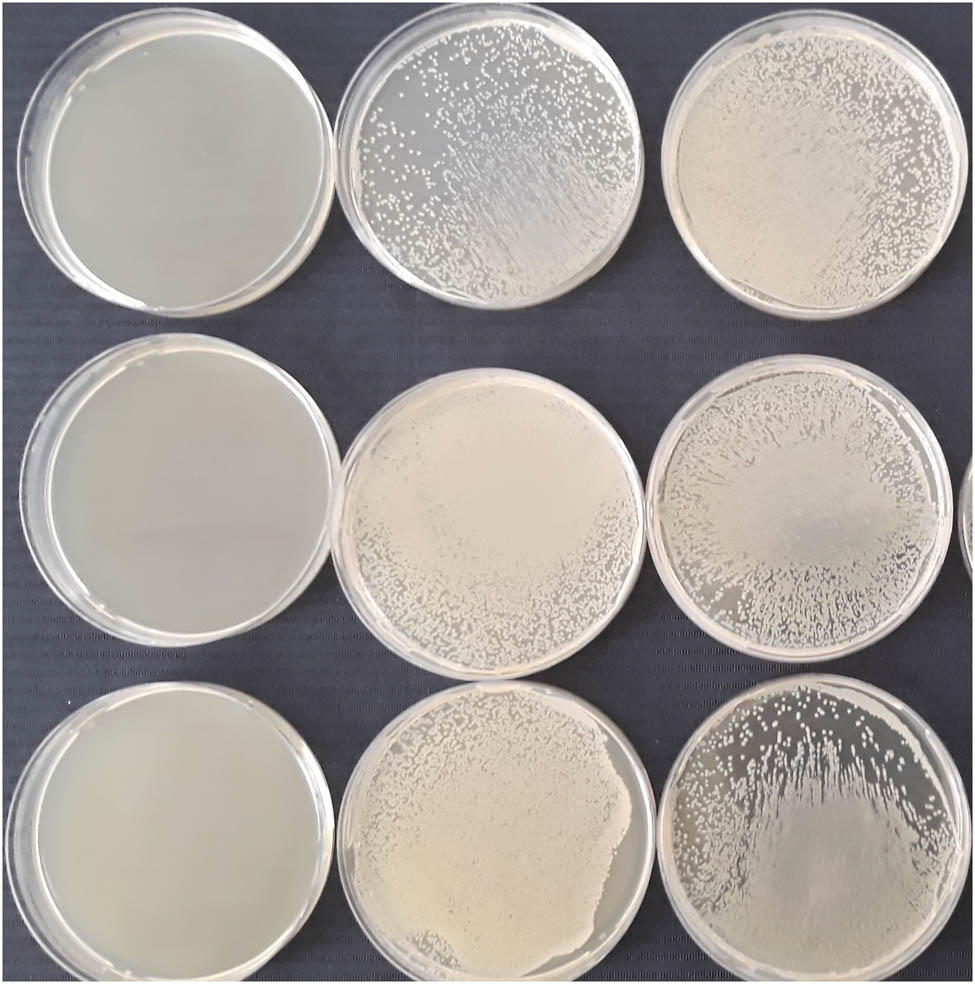

Abstract
Bacterial colonization of male reproductive tissues, cells, and fluids, and the subsequent impact of bacteria on the sperm architecture, activity, and fertilizing potential, has recently gained increased attention from the medical and scientific community. Current evidence strongly emphasizes the fact that the presence of bacteria in semen may have dire consequences on the resulting male fertility. Nevertheless, the molecular basis underlying bacteriospermia-associated suboptimal semen quality is sophisticated, multifactorial, and still needs further understanding. Bacterial adhesion and subsequent sperm agglutination and immobilization represent the most direct pathway of sperm–bacterial interactions. Furthermore, the release of bacterial toxins and leukocytic infiltration, associated with a massive outburst of reactive oxygen species, have been repeatedly associated with sperm dysfunction in bacteria-infested semen. This review serves as a summary of the present knowledge on bacteriospermia-associated male subfertility. Furthermore, we strived to outline the currently available methods for assessing bacterial profiles in semen and to outline the most promising strategies for the prevention and/or management of bacteriospermia in practice.
1 Introduction
Scientific evidence gathered over the past decades strongly indicates that subfertility or infertility represents an increasing issue in the global scenario. This phenomenon is particularly notable in western countries, as revealed by epidemiological studies that show that male reproductive performance has declined by 1.5% per year in the United States [1,2]. Significant alterations to sperm quality have also been reported in European countries, such as Sweden [3], Denmark [4], Austria [5], Poland [6], France [7,8], and Italy [8,9]. Nevertheless, a progressive decrease in sperm quality over the past decades was also observed in Egyptian, Nigerian, Libyan, and Chinese males [10,11]. Despite a variety of currently available advanced diagnostic protocols, treatment, and management options for suboptimal male reproductive performance, infertility has become a significant issue in several species, including humans as well as farm animals [12].
Male infertility is defined as the male’s inability to achieve pregnancy in a fertile female following at least 12 months of regular, unprotected sexual intercourse [13]. As pointed out by Agarwal et al. [14,15], in humans, the cause of infertility lies exclusively with the male in 20–30% of all reported cases, while a male cause contributes to an additional 20% of infertile couples. As opposed to comprehensive reviews on the human species, large-scale reports are very sparse on farm animals. Nevertheless, existing studies indicate that subfertility is increasing in livestock as well [16], with male factor infertility accounting for 40–50% of an overall failure to successfully accomplish fertilization [17].
Fertility issues lead to increased social and psychological distress in humans [18] and present severe consequences on animal welfare and production [13]. Economically speaking, male infertility presents a significant financial burden on patients and the healthcare system [19]. The economic aspect of suboptimal male fertility management is even more amplified in farm animals since ejaculates from a single male may be used for artificial insemination in a large number of females, which is why semen samples from subfertile studs affect conception rates leading to considerable economic losses for farmers [13]. As such, a proper understanding of the causes of subfertility, early detection, and adequate intervention strategies may mitigate the negative consequences of suboptimal human or animal semen quality.
2 The role of bacteriospermia in the etiology of male infertility
Male infertility is a complex health issue that may be caused and/or aggravated by many causes or risk factors. The etiology of male infertility encompasses a wide range of hereditary or acquired causative agents that are often poorly understood, and their elucidation is often imprecise or highly subjective. According to Agarwal et al. [14], the origins of male subfertility may be classified into three general groups. Congenital or genetic causes encompass the cystic fibrosis gene mutation, numerical chromosomal abnormalities such as the Klinefelter syndrome, microdeletions of genes located on the Y chromosome, the Noonan syndrome, the Kallmann syndrome, or chromosomal translocations [20]. Acquired causes include a broad spectrum of factors ranging from traumatic injuries to the reproductive system, tumors, systemic diseases, varicocele to exogenous factors (heat, medication, surgical treatment, and so on), inflammation, oxidative stress, and sexual dysfunction [14,21]. Idiopathic risk factors more relevant to humans are represented by lifestyle choices, such as smoking, diet, stress, and exposure to toxins [22].
Among this large group of factors that may compromise the reproductive potential of males, bacteriospermia has emerged as a link between acquired and idiopathic aspects of male infertility and represents an important yet often-overlooked element that may compromise semen quality in humans as well as animals. Since the very first reports on agglutinating effects of Escherichia coli on spermatozoa [23] and isolation of Brucella from porcine semen published in the 1940s [24], more than 7,000 original papers have emerged to this date. Of these, over 2,700 research studies have been published over the past decade, indicating that the topic has been receiving increased attention from the medical, veterinary, and scientific communities.
Bacteriospermia is defined as the presence of bacteria in the seminal fluid [25] and is clinically acknowledged when bacteria in the ejaculate exceeds 1,000 colony-forming units (CFU)/mL [26]. The condition is often a consequence of acute or chronic bacterial infection of the male urogenital tract accounting for up to 15% of male infertility cases [26]. Various sites of the urogenital system may be affected by bacterial infection, including the prostate, epididymis, testes, and urethra [27], or the infection may be transmitted via sexual intercourse [28]. Bacteriospermia may be caused by both G+ and G− bacteria and Chlamydia spp. or Mycoplasma spp. [25]. While the most common pathogenic bacteria identified as causative agents of urogenital infections and subsequent bacteriospermia are represented by E. coli, Chlamydia trachomatis, Ureaplasma urealyticum, Mycoplasma, Staphylococcus aureus, Streptococci, and Enterococcus faecalis [27], the male urinary system is not completely sterile as it has been already shown that certain bacteria, such as Staphylococcus epidermidis, are present in otherwise healthy subjects [29,30,31,32]. Furthermore, even in healthy individuals, semen may be contaminated by microorganisms during its passage through the genital tract, starting from the testes and expanding all the way to the prepuce and penile foreskin [33]. Particularly in the case of animals, bacteria present in ejaculates may originate from preputial fluids, skin, wool, urine, feces, or respiratory secretions [34]. While it is widely acknowledged that an individual with a good general health status produces semen of good quality [34], collecting and processing ejaculates are not antiseptic procedures. Hence, additional sources of semen contamination may include the artificial vagina, laboratory glassware, equipment, or semen extenders [32,33]. Moreover, contaminated feed and water, bedding, or poor hygiene standards may equally contribute to bacterial contamination of ejaculates [34,35].
The effects of bacteriospermia on the resulting sperm quality are diverse and have been reported by a multitude of studies in several species including bulls [30,36,37], buffaloes [33], rams [31,35], boars [32,34,38], rabbits [39], turkeys [40], stallions [41,42], and humans [26,27,28,29,43]. Most of the studies agree that bacterial contamination of semen may lead to a decreased sperm motility and membrane stability [28,30,31,32,40,44]; alterations to the sperm head, mid-piece, and tail; acrosomal degeneration [28,30,31,32,45,46,47]; a stalled mitochondrial metabolism and ATP synthesis [30,31,40,47]; DNA damage; and phosphatidylserine dislocation [39,40,48,49]. Sperm agglutination [28,50,51], reactive oxygen species (ROS), overgeneration, and lipid peroxidation (LPO) [30,31,39,40] have been frequently associated with bacteriospermia as well. Bacteria present in ejaculates have been reported to trigger a local immune reaction often accompanied by leukocytospermia and secretion of cytokines [26,28,29,52], which have been often associated with a decline in male fertility. Finally, it has been suggested that bacterial infiltration into semen could modify the physicochemical or biochemical properties of the seminal plasma or semen extenders, which may compromise sperm survival in vivo as well as in vitro [32,45,53,54] (Figure 1).

The effects of bacteriospermia on the sperm quality. The effects of bacteriospermia on sperm structure and function are distinct and multifactorial. Most reports have observed decreased sperm motility, alterations to the sperm morphology, and acrosomal degeneration. Frequently observed phenomena include DNA fragmentation and cell death. Sperm agglutination, oxidative stress, and a local immune reaction as a result of bacteriospermia have also been reported. Created with BioRender.com.
Since bacterial infestation of semen is multivariable and complex, specific mechanisms of bacterial action on the quality of male reproductive fluids and cells will be discussed in detail.
2.1 Bacterial adherence
The adhesion process opens the doors for subsequent colonization of semen by bacteria. Bacterial adherence may be considered a crucial factor determining the invasive capability of bacteria and is proportional to the concentration of bacteria in the ejaculate.
An often-observed phenomenon is a bacterial adherence to the acrosome, leading to acrosomal disintegration that will arrest crucial fertilization mechanisms. As Zhang et al. [55] explained, bacterial adherence to the sperm surface may lead to an increased load of cells and thus impair sperm motion. Bacteria immobilized by adherence may furthermore attract other bacteria that will form complexes that agglutinate and form structures that may intervene with the motion of spermatozoa [56]. Subsequent agglutination may induce the secretion of extracellular polymeric substances and initiate biofilm formation [25,46,57]. Furthermore, sperm adhesion may trigger the release of exotoxins that might immobilize male gametes and alter their fertilization potential [58].
Bacterial adherence to host cells is a complex phenomenon that generally requires synchronized participation of different adhesion processes that may occur at the same time or at distinct stages of bacterial colonization. Bacteria able to adhere to the sperm surface contain polymeric adhesive fibers named “pili” or “fimbriae” that enabled first contact and subsequent infestation [59]. Pili are defined as virulence factors that present with the ability to mediate interbacterial aggregation and the formation of biofilms or to facilitate a specific recognition of host–cell receptors [58,59]. While it has been reported that pili play biological roles in the case of commensal microorganisms, the adherence affinity to spermatozoa has been well described in the case of Enterococcus, Bacteroides, Bifidobacterium, Enterobacteriaceae, and Lactobacillus [60].
The molecular mechanism of bacterial adherence is an intricate process that relies on the cooperation of pili, afimbrial adhesins, and interfacial free energy [55]. The phenomenon is furthermore facilitated by the fact that spermatozoa are, per se, rich in superficial glycoprotein receptors and are thus susceptible to bacteria–mediated interactions at the receptor-ligand level [61].
G− bacteria, particularly E. coli, are known for their flagella and pili affinity to mannose receptors [56] that have been discovered on the sperm surface [62]. Type 1 fimbrinae, considered the most versatile virulence factor of uropathogenic E. coli, primarily mediate the attachment to the sperm surface and are involved in the promotion of the formation of intracellular bacterial communities and early stages of biofilm formation [56,61,63]. The essential receptor component in glycoproteins for type 1 fimbriae is a mannose group [25,56] which is located primarily in the sperm head. Another class of adhesins, specifically P fimbriae, is the widely studied mannose-resistant adhesion molecules observed in the majority of uropathogenic isolates [64], and E. coli strains are found in acute prostatitis [57]. The essential minimal active moiety in glycolipids for P-fimbriae is a-D-galp-l-4-9-D-galp (gal gal) [25] located predominantly in the sperm tail.
In the case of G+ bacteria, a common pilus is SpaCBA, which plays a role in bacterial colonization by binding to host cells, mucin, and mucous collagen and inducing bacterial aggregation. This pilus has been observed in Lactobacillus and Corynebacterium, exhibiting an exclusive sperm motility impairment without affecting the morphology or vitality of male reproductive cells [55,65].
Bacterial adhesion may be widely affected and promoted by afimbrial adhesins. According to Zhang et al. [55], a group of proteins called microbial surface components recognizing adhesive matrix molecules have been observed particularly in G+ bacteria. These molecules that are typical for Staphylococci covalently bind to peptidoglycans in the cell wall and target proteins in the host’s extracellular matrix [66]. Furthermore, they play essential roles in bacterial aggregation and induce a strong affinity to selected hydrophobic molecules [67]. Extra colonization benefits are provided by the so-called moonlight proteins that act as adhesins and have been observed in Streptococcus, Lactobacillus, and Staphylococcus isolates [55,68].
Bacterial adherence is significantly affected by inherent physical properties of the bacterial cell wall, such as hydrophobicity, charge distribution, and the area of contact, which are collectively defined as interfacial free energy. Bacterial adhesion is favored if free energy is negative, while positive free energy will act as a barrier between two cellular surfaces. Hence, the process of adherence will stall [69]. Appropriate free energy levels are crucial for the initial phase of bacterial adherence, during which bacteria attached to the sperm surface form a reversible and nonspecific adherence. A correct initial adherence then promotes a proper binding of the adhesins to the surface, leading to an irreversible time-dependent adhesion [70]. Matrix proteins, such as fibrinogen, fibronectin, and vitronectin, support the process of adherence since these act as additional adherent sites.
2.2 Sperm agglutination and immobilization
Sperm agglutination as a consequence of sperm–bacteria interactions may be defined as a process during which motile spermatozoa stick to each other—head-to-head, tail-to-tail, or mid-piece-to-tail. Nonspecific agglutination involving the adherence either of nonmotile spermatozoa to each other or of motile sperm to other cells, debris, or mucus threads may also occur [71].
This process is mediated by the inherent ability of bacteria to attach to each other. The high agglutination potential of bacteria leads to the creation of a more complex architecture called a biofilm, which ensures a more favorable environment for bacterial colonization. Intricate host–bacteria adhesions furthermore allow niches to be occupied by bacteria. At the same time, a solid layer of extracellular polymeric substances as a by-product of bacterial adherence decreases the entry of antibacterial molecules, complicating eventual treatment options for the infection [70,72]. Moreover, high bacterial density in the biofilm enables DNA cross-talks among bacteria, which may result in the spread of drug resistance patterns [72].
The agglutinating process largely depends on the type of pili that catalyzes the initial bacterial adherence to the sperm cell. These fimbriae-dependent interplays may be competitively inhibited by the administration of a specific molecule found in the corresponding receptor. Type 1 fimbrinae which may be inhibited by mannose cause primarily head-to-head agglutination. In the meantime, P-fimbriae are inhibited by gal-gal and are responsible for tail-to-tail agglutination. A mixed agglutination is caused by bacterial strains that contain both types of pili, the activity of which may be inhibited by a mannose/gal-gal combination, supporting the theory that sperm agglutination is receptor dependent. Moreover, it has been suggested that spermatozoa contain a wide variety of superficial receptors, which is why even asymptomatic colonization of the male reproductive system by sperm agglutinating bacteria may lead to interactions that may evolve into agglutination of motile male gametes [59,61,66,69,71] (Figure 2).

The process of bacteria promoted sperm agglutination. The agglutinating process as a result of bacterial presence in semen (a and b) relies on the type of pili that provides for the initial bacterial adherence to the corresponding sperm cell. Type 1 fimbrinae cause primarily head-to-head agglutination, while P-fimbriae are responsible for tail-to-tail agglutination (c). Subsequently, bacteria will release the SAF or the SIF (d) that will fortify the creation of biofilm (e), providing a more favorable environment for bacterial colonization. Inversely, spermatozoa affected by agglutination will exhibit signs of mitochondrial dysfunction, loss of motility, early onset apoptosis and/or necrosis (e). Created with BioRender.com.
As suggested by Monga and Roberts [61], host receptor variability and density on the sperm surface play a critical role in the host’s susceptibility to sperm agglutination. Proteins present in the seminal plasma and vaginal and cervical secretions may interfere with and/or mask receptor saccharides on the sperm surface, representing a barrier obstructing a potential interplay between the bacterium and sperm receptors for adhesion and/or agglutination, providing yet another important role of the reproductive fluids in the sperm protection during their transit within the urogenital system.
The most common molecule involved in the process of sperm agglutination is the sperm agglutinating factor (SAF), which has been isolated and purified from E. coli by Kaur et al. [73] and which blocks sperm motility by agglutination, causes morphological alterations in male gametes, and is spermicidal at higher concentrations. SAF interferes with the 125 kDa sperm receptor using its 71 kDa ligand that binds to both the sperm head and tail. Furthermore, a similarity of purified SAF to glutamate decarboxylase and receptor to major histocompatibility complex class I has been reported [74]. Receptor-specific interactions of SAF primarily target Mg2+-dependent ATPase that becomes competitively inhibited, as well as the surface receptors for cell death by apoptosis [73,74].
Subsequent studies on sperm agglutination also have isolated SAF-related molecules from other bacterial species. Pant et al. [75] uncovered an 80 kDa SAF molecule from Staphylococcus warneri, which also exhibited the ability to inhibit Mg2+ dependent ATPase activity and acted as a contraceptive in murine models. According to Ohri and Prabha [76], a 70 kDa protein is also produced by S. aureus, mediating a tail-to-tail agglutination of spermatozoa.
While sperm agglutination is a prime mechanism of sperm deterioration in the presence of E. coli, Paulson and Polakoski [77] revealed that this bacterium additionally secretes a small soluble ∼20 kDa protein that immobilizes spermatozoa without agglutinating them. Further tests have revealed that this sperm immobilization factor (SIF) is dialyzable and resistant to high or low temperatures. Follow-up studies have reported that E. coli also produces a thermolabile 56 kDa SIF, which recognizes a specific 113 kDa receptor located on the sperm membrane [51,78]. This molecule has detrimental effects on Mg2+-dependent ATPase activity and acrosome reaction induced by calcium ionophore [79].
A 20 kDa sperm immobilization protein isolated from S. aureus recognizes a specific 62 kDa receptor on the sperm surface, which – contrary to SIF from E. coli – could not be dialyzed nor withstand high temperatures [80]. Besides immobilizing spermatozoa in a fast and effective manner, SIF produced by S. aureus exhibited spermicidal effects on the sperm membrane, which was not observed in the case of E. coli-derived SIF [78,79,80].
The process of sperm agglutination and immobilization has been observed in the case of other uropathogens, such as Mycoplasma, Chlamydia trachomatis, and Trichomonas vaginalis [27,50,55,61,81]. Both processes are by and large simultaneous and reversible. However, high concentrations of other cytotoxic molecules released by bacteria may significantly impact the resulting vitality and fertilization potential of male reproductive cells. Spermatozoa affected by agglutination exhibit a high prevalence of morphological abnormalities and are prone to a premature acrosome reaction. Both phenomena have been markedly associated with the disruption of the activity of mitochondrial enzymes (particularly ATPase) crucial for sperm movement [26,27,47,79,82]. Consequently, the mitochondrial function is impaired, followed by an abrupt decrease of the mitochondrial membrane potential and subsequent rupture of mitochondria [28,47]. The resulting release of mitochondrial cytochrome C and ROS may lead to direct sperm apoptosis or necrosis, primarily responsible for decreased quality of semen [48].
2.3 Spermatotoxic bacterial products
Besides a direct contact of bacteria with spermatozoa, detrimental effects of bacteriospermia may be caused by extracellular molecules that are being synthesized and secreted by bacteria, such as lipopolysaccharide (LPS), hemolysins, or quorum sensing (QS) molecules.
LPS is a major component of the G− bacterial cell wall [83]. During bacterial colonization, LPS is released and binds primarily to Toll-like receptor 4, stimulating pathogen-associated molecular pathways. Subsequently, nuclear factor-κB is activated to initiate the transcription of downstream inflammatory factors [84]. LPS has been frequently associated with reproductive toxicity [85,86], by interfering with the expression of pro-apoptotic genes [86,87]; however, recent studies have revealed that in contrast to the transcriptional machinery, LPS primarily affects the behavior of second messengers crucial for sperm function, such as the cyclic adenosine monophosphate (cAMP), Ca2+, and protein phosphorylation [88,89]. Li et al. [90] have unraveled that LPS reduced the intracellular cAMP of sperm independently of the levels of Ca2+ and protein–tyrosine phosphorylation. As such, the primary motility and penetration ability-inhibiting mechanism of LPS may be associated with the reduction of intracellular cAMP since this molecule is a crucial regulator of the sperm activity following ejaculation. Furthermore, as suggested by Zhang et al. [55], LPS-mediated regulation of sperm vitality may be accompanied by an increased generation of ROS and a subsequent disruption of the sperm membrane conformation.
Besides sperm agglutinating and immobilizing factors, uropathogenic E. coli encode a pore-forming toxin called α-hemolysin. α-hemolysin is a strong and ubiquitous cytolysin with the ability to form pores in the host cell membrane, which will ultimately result in cellular lysis [91]. The lysis process is independent of a receptor since α-hemolysin can permeabilize lipid bilayers of varying composition [92,93] and disrupt the colloidal osmotic pressure by forming voltage-dependent ion channels [93,94]. In the case of spermatozoa, hemolytic E. coli strains immobilize spermatozoa more efficiently and at a lower concentration in comparison with nonhemolytic counterparts. These can also induce a higher intracellular ROS production and a decline of the sperm mitochondrial membrane potential through cellular rupture [64,91,95]. Hence, α-hemolysin is released from the bacterial body and only exerts an effect if the bacterium adheres to the sperm surface [55].
Similar to α-hemolysin, β-hemolysin isolated from Enterococcus acts as a pore-forming membrane toxin that impacts the membrane integrity and thus contributes to sperm immobilization [55]. As observed by Qiang et al. [96], membranes of spermatozoa exposed to Enterococci and their toxic products were especially damaged on the head, neck, and the middle piece of the tail. Membranes covering the principal and the end piece of the tail were less damaged in comparison to the head. The head damage accompanied by the release of hydrolytic enzymes further confirms that the acrosomal region is the principal part of the sperm anatomy to be impacted by β-hemolysin and thus provides a link between enterococcal infection and male infertility.
The phenomenon of QS has gained substantial attention not only within the area of microbial communication in a predefined bacterial population but also in the field of interkingdom signaling and pathogenicity. QS is defined as the ability of microorganisms to “sense” their population density through a network of signaling molecules that are released and subsequently responded to. Once a QS concentration threshold is reached, these molecules will coordinate an array of activities, including biofilm formation, bioluminescence, and expression of virulence genes. Different QS molecules, such as the autoinducing peptides or N-acylhomoserine lactones, have been observed in numerous bacterial species such as S. aureus and Pseudomonas aeruginosa [46,97]. According to Rana et al. [33], soluble QS molecules of different bacterial origins may elicit diverse detrimental effects on male gametes. In this study, a reduction in sperm motility coincided in a dose-dependent manner with apoptosis and necrosis and a premature loss of the acrosome via a calcium-dependent mechanism. Since the male reproductive tract and cells are rich in communication receptors prone to interact with QS molecules, QS may become a new facet in the interaction of bacteria with male gametes and represents a putative link between bacterial communication systems and host infertility [46].
Finally, currently available evidence suggests an involvement of nonspecific enzymatic molecules produced by bacteria, such as coagulases, proteases, lipases, and coagulation factors that could play important roles in creating a favorable environment for successful bacterial colonization of male reproductive tissues and fluids [25].
2.4 Leukocytospermia as a cofactor of bacteriospermia
An inherent immune response to infection represents the infiltration of leukocytes to the source of inflammation. Leukocytospermia is acknowledged if the concentration of leukocytes positive for the peroxidase staining exceeds 1 × 106/mL of semen, and the condition is generally linked to the presence of an infection and/or an inflammatory process in semen [26,29,52,98]. As suggested by Fraczek and Kurpisz [28], seminal white blood cells may be detected in the second phase of urogenital infection and are persistently present even following the elimination of the source of inflammation during the third stage of infection. This phenomenon is defined as isolated leukocytospermia [99,100]. However, other conditions may also lead to isolated leukocytospermia, such as varicocele, obesity, smoking, or traumatic injuries [97]. A definitive link between leukocytospermia and a decreased semen quality has to be reinforced yet, since some studies have emphasized a clear association between the presence of seminal leukocytes and alterations to the sperm concentration, motility, viability, DNA, and morphological integrity [26,29,30,31,32,40,101], while others revealed no effect of leukocytospermia on the fertilization potential, particularly with respect to artificial insemination or in vitro fertilization-associated conception rates [102,103].
The Polish team of Fraczek and Kurpisz, regarded as pioneers in elucidating the molecular interplay of bacteriospermia and leukocytospermia, has postulated that leukocyte-inflicted damage to the male gamete may be directed through three processes: (a) a direct attachment to the cell, (b) by phagocytosis, and (c) by extracellular traps (ETs) [28] (Figure 3). Sperm deterioration through all proposed mechanisms of action may occur during leukocytospermia coexisting with bacteriospermia as well as during isolated leukocytospermia. Sperm damage inflicted by white blood cells is more severe during bacteriospermia, since within the innate defense mechanisms, leukocytes release an array of cytotoxic molecules, proteases, and ROS that may inflict further structural and/or functional damage to male reproductive cells [28,29,30,31,99,104].

Leukocyte-inflicted damage to spermatozoa. The process may be directed through an array of processes: a direct attachment of the leukocyte to the sperm cell leading to the release of ROS and pro-inflammatory molecules, by phagocytosis (spermiophagy), by the creation of antisperm antibodies, and by ETs. Created with BioRender.com.
The majority of white blood cells present in semen are represented by macrophages and polymorphonuclear neutrophils, which were originally thought to play a role in the surveillance and phagocytosis of abnormal and/or dead spermatozoa. Nevertheless, their inappropriate activation ignited by a tight adherence to male gametes leads to phagocytosis even of healthy spermatozoa [26,28,98,99,104]. In the first stage of spermiophagy, direct contact of both cells is followed by a tight adhesion of leukocytes to the surface of the sperm head, midpiece, or flagellum. This strong connection allows an entrapment, immobilization, and engulfment of spermatozoa by the cytoplasm of phagocytic cells. As observed by Piasecka et al. [105], active leukocytes formed cluster-like structures that most likely became the center of phagocytosis, capturing and engulfing spermatozoa, providing yet another example of leukocyte cooperation during bacteriospermia. The process is furthermore reinforced by the release of proinflammatory cytokines produced in large amounts by infiltrating macrophages, monocytes, lymphocytes, and dendritic cells [28].
Finally, all the aforementioned events may play a role in the disruption of immunotolerance and subsequent production of autoantibodies against sperm antigens. This pathophysiological phenomenon may be additionally fortified by molecular similarities between different bacterial strains and sperm antigens, as previously demonstrated by Prabha et al. [106] in the case of S. aureus, E. coli, P. aeruginosa , and Proteus mirabilis due to the existence of a common receptor for SIF on spermatozoa and bacteria. The outer core of bacteria often contains mannose, galactose, and N-acetyl glucosamine, which share analogies with carbohydrate moieties on the sperm surface [107], indicating a molecular resemblance between determinants present in male gametes and pathogenic bacteria. It seems that heat shock proteins (HSPs) also play a pivotal role in Chlamydia-associated molecular mimicry since these chaperones are released in response to stressful stimuli, such as in the case of bacterial infection [108,109]. The phenomenon is fortified by a 50% homology that is shared between the bacterial 60 kDa HSP family (bacterial HSP60), regarded as prime antigenic determinants during infection, and mammalian HSP60 [110]. The resulting cross-reactivity may lead to the development of inflammation and/or autoimmune reactions [111], which have been previously associated with male reproductive dysfunction through the induction of antisperm antibodies by seminal IgA antibodies or serum IgG antibodies [112]. However, the most recent studies are not unanimous regarding the association between the presence of chlamydial HSP antibodies and the presence of antisperm antibodies [108,112], with some authors reporting an association between them [108] in contrast to others [110,112].
A concomitant mechanism of an active immune response lies in the secretion of an array of cytokines, which present with the ability to inflict damage to male reproductive cells. As pointed out by Fraczek and Kurpisz [28], it is safe to assume that these biomolecules act within a network, which makes it difficult to define a specific spermatotoxicity of just one cytokine. As such, it seems plausible to hypothesize that the toxicity of one immunomolecule can be modulated in the presence of other molecular components of the immune system. Besides acting as prooxidants and inducing sperm damage primarily through LPO of the plasma membrane [104], it has been suggested that cytokines actively participate in the induction of the apoptotic machinery in ejaculated spermatozoa. Among different pro-inflammatory cytokines, tumor necrosis factor (TNF) α, one of the predominant cytokines released during inflammation and/or infection, is most often believed to act as an inducer of sperm apoptosis, phosphatidylserine translocation, or DNA fragmentation [113,114]. The proapoptotic behavior of TNF α may be further mediated via ROS or nitric oxide [114]. Within the large family of proinflammatory interleukins (ILs), IL-1b, IL-6, IL-8, IL-12, and IL-18 seem to play an important role in mediating inflammation-inflicted damage to male gametes. Their increased levels in response to bacterial overload in ejaculates have been correlated with a decreased sperm quality. It has been hypothesized that these immunomolecules could act as predictive biomarkers of ailments associated with bacteriospermia, such as prostatitis or male accessory gland infection (MAGI) [30,31,40,115,116,117]. Similar to TNF α, ILs are closely interconnected with an oxidative outburst [30,31,40] and a subsequent decrease in sperm motility is accompanied by an increased risk for DNA fragmentation [118,119].
The creation of ETs by activated leukocytes has been recently uncovered as a novel type of response by the immune system to the presence of infectious agents, which is catalyzed by the breakdown of the plasma membrane and a subsequent release of chromatin fibers following the disintegration of nuclear plasma (nuclear origin) or mitochondrial matrix (mitochondrial origin) [120,121]. While the backbone of ETs is composed of DNA and histones, the interior is embedded with a wide array of biomolecules such as lactoferrin, myeloperoxidase, defensins, bacterial permeability-increasing protein, proteases, or elastase, all of which present with significant antibacterial properties [121,122]. Contrary to the original beliefs that ETs were exclusive to polymorphonuclear neutrophils, macrophages, eosinophils, monocytes, and mast cells can also release ETs [123]. Depending on the cell type, ETs vary in shape and appearance, ranging from a diffuse appearance of fine chromatin fibers (such as in the case of monocytes) to a more spherical and compact decondensed chromatin (such as in the case of polymorphonuclear neutrophils) [121]. As unraveled by Schulz et al. [121] and Zambrano et al. [124], physical contact between a white blood cell and a sperm cell leads to rapid activation of the leukocyte, initiating ET formation. ET structures will then engulf the sperm head, midpiece, or flagellum, which is accompanied by the formation of small aggregates. ET fibers cause a physical blockage of male gametes, rapidly decreasing their motility. The process is further aggravated by the initiation of phagocytosis, degranulation, and activation of the cytokine communication network. Taken together, activation of the innate immune system as a response to infection or inflammation might lead to the formation of ETs, which will respond against their own male gametes as if these were recognized as potentially pathogenic agents. Since the release of ETs is a relatively newly discovered defense strategy, specific molecular mechanisms of action during the pathophysiological process of male subfertility need to be elucidated further.
2.5 Oxidative stress
Physiological and pathological roles of ROS in sperm physiology have become indisputable in affecting the male reproductive potential in health and disease. While low concentrations of ROS play an indispensable role in sperm maturation, capacitation, acrosome reaction, and fertilization, ROS overproduction and the resulting oxidative stress have been repeatedly observed in numerous male reproductive pathologies [14,21,22,28,58,104,114,125,126].
Bacterial contamination of semen has been frequently associated with increased oxidative pressure and an imbalance between ROS production and inherent antioxidant protective mechanisms of male reproductive cells, tissues, and fluids [125,126]. Generally speaking, the sources of ROS in bacteria-infested semen may be divided into three categories: (a) bacterial metabolism or products, (b) immune response and activated leukocytes, and (c) damaged spermatozoa.
The extent of ROS production by bacterial action by and large depends on a set of factors, such as the bacterial load and diversity, as well as the type of infecting, contaminating, or colonizing bacterial strain [28]. Aerobic metabolism of spermatozoa and aerobic and facultative anaerobic bacteria predestines them to produce ROS as their metabolic by-products [30]. Even anaerobic bacteria can deploy low-potential electron-transfer pathways, suggesting they be possible producers of reactive intermediates [127]. Superoxide, as well as hydrogen peroxide, have been reported to be released by a variety of potentially uropathogenic bacteria, such as S. aureus [128], U. urealyticum [129], Bacteroides ureolyticus [130], and E. faecalis [131], additional concentrations of which may contribute to the progression of oxidative damage to spermatozoa. As observed by Wang et al. [132], under in vitro conditions, several known pathogens and conditionally pathogenic species may be important inducers of oxidative stress responsible for the destruction particularly of the sperm membranes. Furthermore, virulence factors and toxic metabolites, such as LPS or hemolysins, may stimulate further ROS production by activated leukocytes.
The most predominant source of ROS are peroxidase-positive leukocytes, mainly polymorphonuclear neutrophilic granulocytes, which are activated during the inflammatory process [133]. Following infiltration of infectious agents, the initial immune reaction lies in an increase of seminal white blood cells [134,135]. A subsequent inherent response aimed to dispose of the pathogen results in an increased release of ROS from the activated leukocytes [135]. Two pathways have been suggested to play a pivotal role in the activation of seminal leukocytes during infection. The first lies in an increase of NADPH through the hexose monophosphate shunt. The second route is represented by a respiratory burst, which primarily acts as a protective mechanism during the infection [132,133,135]. Nevertheless, excessive infiltration and activation of seminal white blood cells can lead to concentrations of ROS that exceed a required level for normal physiological sperm functions, possibly leading to an impairment in the quality of semen, sperm concentration, and morphology [136].
According to Roca et al. [137], independently from naturally present abnormal sperm as a result of impaired spermatogenesis, large amounts of damaged or dead spermatozoa become a “silent killer” for viable male gametes. Deleterious effects of dead spermatozoa lie in the extracellular release of ROS (particularly hydrogen peroxide), which may cause irreversible damage to the plasma membrane of the viable sperm. Live spermatozoa affected by the release of the intracellular content from damaged or dead counterparts will then exhibit phosphatidylserine exteriorization and/or DNA breaks that would eventually lead to death by apoptosis or necrosis [137]. Necrotic cell death represents a more concerning phenomenon to the surrounding viable spermatozoa, as the process involves the loss of homeostasis by the rupture of the cell membrane and subsequent contamination of the extracellular environment by potentially spermatotoxic metabolites and the creation of sperm granulomas that may trigger an immune response [138,139].
Regardless of the sources of ROS, oxidative stress has become one of the leading causes of damage to the structural integrity and/or functional activity of the male reproductive cell. Sperm membranes are predominantly assembled of polyunsaturated fatty acids (PUFAs), which maintain a proper membrane fluidity, and are highly susceptible to oxidative overload [140]. Excessive amounts of ROS attack the double bonds present in PUFAs during the process of LPO, which will have a substantial impact on the semipermeable characteristics of the membrane, transport, and signaling processes, and enzymatic and receptor activities. Subsequently, the membrane loses its properties critical for normal sperm motion and fertilization [140,141]. The set of domino reactions involved in LPO will ultimately lead to the damage of DNA and proteins through the production of lipid peroxyl or alkoxyl radicals. Oxidative damage to the sperm DNA will occur primarily through base modifications, single and double-strand breaks, or crosslinks [142]. In the meantime, oxidative insults to proteins may result in amino acid modifications, the disintegration of the peptide chain, altered electric charge, and tolerance to proteolysis [143]. As reported by Mammoto et al. [144], increased levels of protein carbonyls in spermatozoa may lead to a decreased sperm capacity to penetrate the zona pellucida and obstructions in the sperm–egg binding and fusion process. Moreover, excessive ROS amounts may trigger the xanthine and xanthine oxidase system and downregulate the ATP synthesis, which may ultimately lead to a stall in sperm metabolism and lead to a subsequent cell death [125,140].
2.6 Cell death
Under physiological conditions, programmed cell death plays an essential role in assuring a selective deletion of male reproductive cells that have been affected by oxidative stress and are carrying fragmented DNA. Nevertheless, overactivation of the apoptotic cascade has been previously strongly associated with impaired sperm motion and morphology and with a decreased capability of spermatozoa to accomplish capacitation and successfully penetrate the ovum [145].
The potential involvement of bacteria in the promotion of apoptotic processes has been indicated by the number of studies revealing increased expression patterns of early and/or late apoptotic markers such as phosphatidylserine dislocation or TUNEL positivity in spermatozoa exposed to pathogenic as well as conditionally pathogenic bacterial species [39,47,49,146]. Furthermore, correlation studies on subjects with bacterial infection have observed an increased incidence of ultrastructural morphological changes typical of apoptosis or necrosis [39,40,147]. What is more, Fracek et al. [148] reported a simultaneous induction of complete apoptosis and necrosis in spermatozoa from normozoospermic subjects resulting only from simple contact with bacterial agents, even without the mediation of leukocytes.
Previous studies suggest that the principal pro-apoptotic mechanism of bacteriospermia may be linked to the interaction of bacterial endotoxins, such as porins, LPS, or peptidoglycans with Toll-like receptors 2 and 4, which are to be found on the sperm surface [149]. Exposure of spermatozoa to bacterial toxins may lead to an oxidative outburst and subsequent mitochondrial depolarization followed by rupture and caspase 3-mediated sperm apoptosis [150]. Furthermore, the immune response may be involved in sperm cell death through the cytokine network. Precisely, it has been speculated that IL-6, IL-8, IL-1b, or IL-18 could activate the Fas/Fas ligand complex located on the sperm membrane, followed by the initiation of caspase 8-driven cascade of events leading to DNA fragmentation and apoptosis [118].
2.7 Alterations to the biochemical milieu
Besides a direct spermatotoxic effect that bacteria and their products may exert on sperm biology, several studies that have recently emerged emphasize an indirect capability of bacteria to change the properties of the seminal plasma, thus rendering the medium to carry, protect, and nourish spermatozoa after ejaculation to be less favorable for their survival. As suggested by Ďuračka et al. [53] and Meena et al. [151], bacteria may compete for nutrients with spermatozoa as well as among each other, which is why a primary synergic effect of various opportunistic pathogenic bacteria may completely deprive nutrients present in the seminal plasma that otherwise would have been available for the sperm metabolism.
A correlation analysis revealed a significant negative association between the bacterial load and Mg levels in the seminal plasma. As Mg is essential for ATP synthesis, its decreased levels may be ultimately responsible for a decline in sperm motility [152]. Low Mg availability may further affect the activity of transaminases and phosphatases necessary for a proper sperm metabolism, which was confirmed by negative correlations among the activity of alanine transaminase, alkaline phosphatase, and bacterial load of semen, accompanied by a concomitant decrease of sperm motility [153]. The ability of bacteria to actively utilize nutrients at the expense of spermatozoa was also confirmed by an in vitro study, which revealed that a continuous decrease of magnesium and Ca available in a sperm culture medium by various Staphylococcus isolates was accompanied by the loss of sperm motility [49]. Accordingly, low levels of Ca and Mg have been previously detected in subjects suffering from reproductive ailments of different etiologies [154,155,156].
According to Ďuračka et al. [53], negative associations were also found between the presence of bacteria in semen and the levels of albumin or uric acid, which are major nitrogen compounds acting as secondary antioxidants and transport molecules ensuring a proper environment for an optimal sperm functionality [157].
Although preliminary, these pivotal findings strongly indicate that the bacterial load and/or diversity may modulate the seminal plasma composition, leading to insufficient or ineffective sperm nutrition and/or protection. As such, more studies are necessary to elucidate further side effects of bacterial metabolism on sperm survival.
3 Most important bacterial uropathogens
E. coli commonly inhabits the gastrointestinal tract of humans and warm-blooded animals, existing in commensal, symbiotic, and pathogenic relationships with its hosts. However, even commensal strains may promote a state of disease in immunocompromised organisms. A frequent occurrence of E. coli in semen makes it the most researched bacterium regarding suboptimal sperm quality. It appears that pili and flagella represent a key virulence factor of E. coli-associated pathogenicity toward spermatozoa. It has been previously shown that almost 75% of E. coli semen isolates matched urinary serotypes, while flagellar isolates prevailed [158]. Head-to-head sperm agglutination was observed in type-1 fimbriated strains because of mannose residues in the sperm head, while tail-to-tail sperm agglutination was noticed in P-fimbriated strains [61]. Nevertheless, different strains may affect different sperm structures or functions at different concentrations. Particularly, hemolytic E. coli strains pose a higher threat to sperm quality compared to non-hemolytic strains, even at lower concentrations [95].
Staphylococcus sp. has been identified in ejaculates stemming from humans [159], bulls [30], rams [31], boars [32], turkeys [40], roosters [160], stallions [42], and bucks [161]. Despite the fact that staphylococci belong to the most identified bacteria in semen, numerous species have been reported to act as normal components of the skin microflora. S. epidermidis has been previously isolated from 64% of human semen samples, while no changes in sperm motility were found [162]. Conversely, some studies emphasize the unfavorable effects of skin staphylococci on spermatozoa triggered by ROS overgeneration [30,163]. Currently, S. aureus belongs to the most researched species possessing several known factors of virulence, including enterotoxins, lipoteichoic acid, and toxic shock syndrome toxin 1. A further report indicates that S. aureus has the potential to avoid ETs by releasing nucleases and adenosine synthases. These enzymes convert ET structures to deoxyadenosine, which will induce apoptosis of immune cells through the activation of caspase 3 [164].
Even though Enterococcus spp. is listed among the characteristic representatives of gut microflora, an array of studies has provided evidence to suggest that this bacterium could act as an undesirable cause of male subfertility or infertility. A recent meta-analysis [165] summarized publications reporting on the presence of Enterococcus spp. in human semen, according to which 17 of 18 studies detected the presence of this bacterium in specimens from men attending fertility clinics. In addition, Moretti et al. [166] have revealed a significant decrease in sperm concentration and motility in patients who tested positive for E. faecalis. Similar to E. coli, flagella and pili play a major role in the pathogenicity of Enterococcus spp. to other cells and contribute to cell aggregation. In their study, Mehta et al. [167] speculated if direct cell-to-cell contact or metabolic products could be responsible for compromised semen quality in specimens carrying E. faecalis. Likewise, Villegas et al. [168] indicated that toxic metabolic products of E. faecalis released by their proliferative activity and direct contact increased the resulting cytotoxic effect. According to Fraczek et al. [148], E. faecalis was identified in 13.8% cases of healthy young normozoospermic donors with asymptomatic bacteriospermia. At the same time, the sperm quality parameters such as sperm concentration, membrane integrity, mitochondrial membrane potential, and DNA integrity were impaired when compared to the control group without any bacterial presence.
Previous studies have revealed that both healthy donors and patients with prostatitis faced the presence of coryneform bacteria in semen. Although Türk et al. [169] identified coryneform bacteria in 76% of patients suffering from prostatitis, the bacteria were also present in 83% of cases of the control group, which makes their presence in semen unpredictable toward the fertility potential. Generally, coryneform bacteria are considered to be commensals of the urethra or lower urogenital tract. An invasion of the upper urogenital tract and resulting prostatitis may turn their behavior into a saprophytic one. Corynebacterium glucuronolyticum (formerly known as Corynebacterium seminale) was previously reported to act as an opportunistic pathogen with an increased potential to cause male urethritis syndrome [170], monomicrobial paucisymptomatic bacterial prostatitis [171], or encrusted cystitis even without the presence of predisposing factors [172]. A few studies [65,173] have evaluated the impact of C. glucuronolyticum on basic semen parameters and stated that this bacterium was the most abundant species among the semen samples from infertile men. Meštrović et al. [170] designed a prospective pretreatment and posttreatment investigation with a strict criterion regarding the involvement of the semen specimens with a monoculture of C. glucuronolyticum. Their analysis showed a significantly increased percentage of spermatozoa with neck and mid-piece defects. Following treatment, only an improvement in sperm vitality was observed. Therefore, the effect of coryneform bacteria on sperm quality remains indefinite. Even though an array of studies has tried to express the involvement of specific bacterial species in the resulting sperm functionality, the majority of semen samples are still inhabited by a variety of different microorganisms, acting in a relatively synchronized and symbiotic manner.
Lactobacillus, the largest genus among bacteria presenting with the ability to produce lactic acid, has been defined as a nonpathogenic component of intestinal and urogenital floras. Generally, the presence of lactobacilli has not been associated with diseases. The principal role of Lactobacillus species in the vaginal tract is indisputably to maintain a physiologically normal vaginal microbiota and thus prevent possible colonization of foreign bacteria [174]. However, only a few studies have focused their attention on the effect of lactobacilli on sperm quality. Lactobacilli is able to adhere to mucous membranes. Nevertheless, the controversial question remains if these bacteria may adhere to the sperm surface and thereby impair the fertilization potential, as recently discussed by Zhang et al. [55]. Like other species, the concentration of lactobacilli is a key factor in their pathogenic or probiotic effects on spermatozoa. In other words, the higher the lactobacilli concentration, the greater their adherence to male gametes. Vaginal lactobacilli may act as a selector of the most viable spermatozoa during natural mating. Slowly moving spermatozoa or sperm cells with morphological aberrations will be “caught” and agglutinated. However, any bacterial intervention during artificial insemination may block successful fertilization. Particularly, the sperm DNA is susceptible to bacterial presence following thawing [175].
Baud et al. [43] studied the microbiota of human ejaculates, encompassing 26 normozoospermic and 68 samples with at least one abnormality. The authors observed that Lactobacillus prevailed in samples with normal sperm morphology. Similar results were observed by Weng et al. [176], who defined Lactobacillus as the most prevalent group, particularly in the samples accomplishing the criteria for normal semen quality. Interesting research was conducted by Barbonetti et al. [177], who analyzed whether a combination of three selected strains of Lactobacillus could prevent in vitro Fe2+-induced LPO. The authors selected L. brevis, L. salivarius, and L. plantarum strains, considering them as the prevailing bacterial representation on the surface of the vaginal mucosa, preventing urinary tract infections and antioxidant properties of lactobacilli. This study showed that the presence of Lactobacillus species at a concentration of 1 × 108 CFU had the potential to restrain LPO and significantly maintain sperm motility and viability under induced oxidative stress.
Table 1 provides the strongest consensus effects of different types of bacteria across original reports published on the topic.
Leading consensual effects of different bacterial species on the sperm structural integrity and functional activity
| Effect | Bacterium/Bacteria | References |
|---|---|---|
| Inhibition of sperm motility | C. trachomatis | [81,178,179,180,181,182,183,184,185,195] |
| Mycoplasma spp. | [178,184,186,187,188,189] | |
| E. coli | [50,146,166,168,188,189,190,191,192,193,194] | |
| S. aureus | [30,49,66,168,188,189,194,195,196,197,198,199,200,201,202,203] | |
| U. urealyticum | [179,188,189,195,204,205,206,207] | |
| E. faecalis | [39,166,201,208,209] | |
| P. aeruginosa | [207,210,211,212] | |
| Damage to the sperm membrane | E. coli | [47,56,146,166,190,192,213,214,215,216,217] |
| Staphylococcus spp. | [39,47,163,168,218] | |
| Enterococcus spp. | [96] | |
| P. aeruginosa | [207,210,211,212] | |
| U. urealyticum | [206,219,220] | |
| C. trachomatis | [81,150,182,221,222] | |
| P. aeruginosa | [207,210,212] | |
| Mitochondrial dysfunction | E. coli | [47,50,146,192] |
| Staphylococcus spp. | [30,47,49,197,163] | |
| P. aeruginosa | [207,212] | |
| U. urealyticum | [223,224] | |
| Sperm morphology abnormalities | E. coli | [78,190,194,213,225,226] |
| Staphylococcus spp. | [194,196,203,227] | |
| E. faecalis | [167,227] | |
| U. urealyticum | [179,228,229,230,231] | |
| C. trachomatis | [185,186,232] | |
| Mycoplasma spp. | [179,187,230] | |
| DNA fragmentation | Mycoplasma spp. | [178,179,187,233] |
| E. coli | [50,216] | |
| Staphylococcus spp. | [30,49,189] | |
| C. trachomatis | [150,178,233,234,235,236] | |
| U. urealyticum | [236,237,238] | |
| Sperm agglutination/aggregation/immobilization | E. coli | [6,23,61,74,239,240] |
| Staphylococcus spp. | [66,75,76,80,195,202] |
4 Bacteriospermia in practice
Approximately 6.9–8% of sexually active men have been estimated to suffer from a urogenital infection [241]. Among the most commonly diagnosed ailments of the urogenital tract, chronic urethritis, prostatitis syndrome, epididymitis, and orchitis play a prime role. Furthermore, viral infections may contribute to chronic inflammation and thus decrease the fertility potential [242].
The World Health Organization (WHO) has published criteria to diagnose MAGI based on physical, urine, and semen examinations. In particular, medical history of any previous urinary tract infection, sexually transmitted infection, or epididymitis should demand attention. The physical examination findings include a thickened and tender epididymis, a thickened spermatic cord, and an abnormal digital rectal examination. Urine is collected following prostate massaging, while any abnormalities and the presence of Chlamydia trachomatis are being monitored. Positive findings from the semen evaluation include leukocytospermia, a positive semen culture for any pathogens, a positive C. trachomatis test, increased inflammatory markers or ROS levels, and any abnormalities in the biochemical profile of the seminal plasma. MAGI is diagnosed when two of three of the aforementioned findings are positive alongside oligozoospermia, and/or asthenozoospermia, and/or teratozoospermia [243]. Chronic prostatitis is characterized by at least 10 times higher bacterial count following a prostate massage. A significantly elevated bacterial count may occur in 50% of ejaculates from prostatitis patients, while leukocytospermia and increased concentrations of IL 8 are frequently observed as well [244].
Asymptomatic genital tract inflammation used to be mistaken for chronic prostatitis. This ailment differed from prostatitis by no changes in the volume and pH of semen, frequent damage to the flagellar membrane, no changes to the seminal zinc concentration, and decreased levels of α-glucosidase [244].
According to Schiefer [245] and Cottell et al. [246], common urethral commensals present in the ejaculate do not necessarily mean a genital infection. Therefore, a significant bacteriospermia was defined as 103 CFU in 1 milliliter of ejaculate [247]. Leukocytospermia has been previously observed in bacteriospermic patients. Furthermore, Domes et al. [29] have associated the presence of neutrophilic granulocytes with suboptimal semen quality parameters, including sperm DNA integrity.
Semen examination, according to the WHO recommendations, is a crucial factor in detecting any infection or inflammation in the male urogenital tract. However, basic semen parameters do not have the strength to indicate infectious or inflammatory processes. Although volume, pH, and the biochemical profile of the seminal plasma are included in the differential diagnosis, they only provide information about the accessory glands and their function. The presence of IgG and IgA immunoglobulins in semen may indicate sperm agglutination. An ongoing inflammatory process is furthermore very well indicated by the presence of granulocyte elastase and proinflammatory cytokines [244].
Usually, urine samples are tested for the presence of urinary pathogens. Clinically, the presence of commensals in urine, e.g., S. epidermidis or S. viridans, is insignificant. Conversely, Escherichia sp., Enterococcus sp., Proteus sp., Mycoplasma sp., Ureaplasma sp., Klebsiella sp., and Staphylococcus spp. may cause an infection similar to obligatory pathogens [245]. Moreover, the result of the microbial profile may be affected by the transport, sampling, and processing time and by insufficient prepuce cleaning. It is also recommended to urinate before masturbation. According to recent recommendations, the most reliable results are obtained when both bacterial culture and Polymerase chain reaction (PCR)-based microbial analysis are performed. Sexually transmitted pathogens are difficult to cultivate on agar plates [244]. Table 2 displays currently published studies concerning bacteriospermic specimens, identified bacteria, and their effect on sperm quality parameters.
Current studies concerning bacteriospermia, identified bacteria and their consequences on semen quality
| Number of samples | Identified bacteria and their frequency | Effect on spermatozoa quality | References |
|---|---|---|---|
| n = 39 (infertile) | S. haemolyticus (38%) | ↓Sperm concentration and progressive motility in case of E. coli, U. urealyticum, and S. aureus | [188] |
| Peptostreptococcus (21%) | |||
| E. faecalis (20%) | |||
| E. coli (20%) | |||
| Ureaplasma urealyticum (17%) | ↓Vitality in case of U. urealyticum | ||
| Mycoplasma hominis (9%) | ↓Morphology in case of S. aureus | ||
| S. aureus (9%) | |||
| Bacteroides fragilis (2%) | |||
| n = 454 (infertile, symptomatic chronic prostatitis) | Chlamydia trachomatis | ↑ pH, ↓ sperm concentration, motility, morphology | [248] |
| n = 707 (fertile, symptomatic chronic prostatitis) | Enterococcus spp. (37%) | ↑ pH | |
| S. saprophyticus (26%) | |||
| E. coli (18%) | |||
| Group B streptococcus (10%) | |||
| Klebsiella sp. (7%) | |||
| Serratia sp. (2%) | |||
| n = 118 (fertile, asymptomatic) | Mycoplasma sp. (22%) | ↓Sperm concentration, total sperm count, | [249] |
| Ureaplasma sp. (35%) | ↓Motility and morphology in case of Mycoplasma | ||
| Chlamydia sp. (32%) | |||
| n = 1,650 (infertile, asymptomatic) | C. trachomatis (1.6%) | ↑Sperm DNA fragmentation in case of U. urealyticum and M. genitalium | [250] |
| M. genitalium (3.1%) | |||
| N. gonorrhoeae (0.4%) | |||
| U. urealyticum (86%) | |||
| Mixed infection (8.9%) | |||
| n = 60 (infertile, asymptomatic) | E. faecalis (25%) | ↓Sperm concentration, total and progressive motility, viability, morphology | [251] |
| S. agalactiae (16.7%) | |||
| E. coli (16.7%) | ↑Sperm DNA fragmentation | ||
| S. haemolyticus (11.7%) | Leukocytospermia | ||
| S. aureus (8.3%) | |||
| Proteus spp. (6.7%) | |||
| K. pneumoniae (5%) | |||
| Multibacterial (10%) | |||
| n = 29 (infertile, symptoms not specified) | S. aureus (27.6%) | Leukocytospermia | [200] |
| S. epidermidis (17.2%) | ↓Sperm concentration, total and progressive motility, fertilization rate | ||
| S. haemolyticus (13.8%) | |||
| E. coli (20.7) | Sperm protamine deficiency | ||
| E. faecalis (13.8%) | |||
| S. agalactiae (6.9%) | |||
| n = 36 (infertile, asymptomatic) | S. aureus (38.9%) | ↓Sperm motility, morphology | [252] |
| S. saprophyticus (22.2%) | |||
| E. coli (16.7%) | |||
| P. mirabilis (8.3%) | |||
| P. vulgaris and K. pneumoniae (5.6% for each) | |||
| P. aeruginosa (2.8%) | |||
| n = 1,200 (nonazoospermic subfertile, majority were asymptomatic) | E. faecalis (56%) | ↑Sperm DNA fragmentation | [29] |
| E. coli (16%) | |||
| Group B streptococcus (13%) | |||
| S. aureus (5%) | |||
| K. pneumoniae (2.2%) | |||
| P. mirabilis (1.7%) | |||
| Citrobacter koseri (1.5%) | |||
| Morganella morganii (1.3%) | |||
| n = 28 (infertile, asymptomatic) | E. faecalis (30%) | [201] | |
| Coagulase-negative Staphylococcus (23.3%) | |||
| S. aureus (20%) | |||
| E. coli (10%) | |||
| K. pneumoniae and Proteus sp. (6.66% for each) | |||
| Citrobacter sp. (3.3%) | |||
| n = 52 (fertile and normozoospermic, asymptomatic) | Coagulase-negative Staphylococcus (22.9%) | ↓Sperm concentration, motility, morphology, membrane integrity | [42] |
| Streptococcus (18.3%) | ↓Viability and total sperm count only in case of Leukocytospermia | ||
| E. faecalis, E. faecium (13.8%) | |||
| C. glucuronolyticum, C. striatum, C. propinquum (16.5%) | ↑Sperm DNA fragmentation | ||
| E. coli, P. mirabilis (3.7%) | |||
| Anaerobic G+ (6.4%) | |||
| Anaerobic G− (13.8%) | |||
| n = 31 (infertile, asymptomatic) | C. trachomatis | ↓Sperm motility, concentration, morphology | [253] |
| M. hominis | |||
| U. urealyticum | |||
| n = 92 (infertile, asymptomatic) | S. aureus (28.3%) | ↓Total sperm count, motility, morphology | [194] |
| E. coli (19.6%) | Immobilization in case of E. coli | ||
| S. saprophyticus (13.0%) | |||
| P. mirabilis, P. vulgaris, and Klebsiella spp. (10.8% for each) | |||
| P. aeruginosa (6.5%) | |||
| n = 60 (infertile, asymptomatic with leukocytospermia) | C. trachomatis (41.7%) | ↑ pH | [254] |
| U. urealyticum (58.3%) | ↓Volume, sperm motility, viability |
Each publication contains information about number of bacteriospermic specimens, their origin considering fertility or infertility, with or without symptoms, identified bacteria on the species level (if specified in publication), frequency of bacterial occurrence, effect of all identified bacteria or specified to single species, and references.
5 Methods for the detection of bacteria in semen
Precise identification of bacterial pathogens is an essential assignment of each microbiological laboratory to aim for appropriate therapy. Conventional identification based on the Gram staining, bacterial cultures, and biochemical properties of bacterial isolates provides, in terms of accuracy, reliable results with good affordability, thanks to which these represent the “gold standard” [255]. However, their use is considerably limited by a possible nonspecific biochemical activity of microorganisms or closely related bacterial species. The usual duration of such tests requires 48–72 h for the cultivation of normally growing bacteria, while the identification of slowly growing bacteria may last for weeks [256], and nonculturable bacterial pathogens stay undetected.
Modern methods of bacterial identification retain a high sensitivity and specificity, while a small amount of sample is consumed to identify the exact species, which is particularly welcome in the diagnosis of bacteriospermia when the sample volume is often limited [176,257]. PCR-based diagnostic methods are referred to as the “new gold standard” in the molecular identification of microorganisms. At the same time, these are also widely used for the detection of virulence factors as well as resistance genes [258]. Routine PCR diagnostics has allowed to develop various modifications. Currently, quantitative PCR (qPCR) represents the most used modification in routine PCR diagnostics, which is specified by the possibility of amplifying more than one sequence during a single PCR reaction [259,260]. Real-time qPCR comes along with faster results without the necessity for additional analysis.
The success of assisted reproductive technology is particularly sensitive to the presence of bacteria. Contaminated cultures of gametes may cause damage or even loss of embryos. Therefore, a rapid and accurate bacterial screening through real-time qPCR may prevent unsuccessful fertilization [261,262]. The high sensitivity of PCR methods also allows the detection of even a low bacterial load in specimens collected from asymptomatic individuals [263].
A new milestone in microbial screening provides the next-generation sequencing. The 16 S ribosomal RNA, a component of the 30 S subunit of the bacterial ribosome, contains highly conserved and hypervariable regions (V1-V9), which allow very accurate identification and specific taxonomic classification. One limitation lies in the actual databases of the 16 S rRNA sequences [264]. Another limitation represents the financial burden of this method. Besides material and equipment, sequencing demands software for the visualization of the results, a database for comparing the obtained results, bioinformatic knowledge, and experience to design the reaction and interpret the collected data [265].
Matrix-assisted laser desorption/ionization–time-of-flight mass spectrometry (MALDI-TOF MS) has been developed for a routine application in rapid microbial diagnostics. This technique utilizes a soft ionization and separation of charged particles according to their molecular properties in magnetic and electric fields. The samples are being ionized by a laser, which is necessary to avoid thermal disintegration. For this purpose, the matrix is added to the examined sample to absorb a strong laser nitrogen beam. The molecules are transferred during excitation from the matrix to the analyte, which is then protonated or deprotonated, creating molecules with a uniform charge. Particles will pass through the vacuumed TOF tube according to their charge and mass, and the detector at the end of the tube measures the time of flight of each ion, as light ions pass faster than the heavier ones [266].
MALDI-TOF MS must contain three basic components: a source of ions and ionization to convert molecules to a gaseous state; a spectrophotometer to separate the ions based on their mass/charge ratio; and software and database to process and compare the obtained results with a database [266]. Currently, molecules ranging from 100 to 100,000 Da can be analyzed. Highly specific results are obtained by the comparison of mass peaks, which is specific for each organism. Therefore, such a protein profile has its own “fingerprint.” The only expensive investment lies in the initial costs of purchasing the machine.
According to Singhal et al. [267], only a few colonies are needed to identify microorganisms, which shortens the diagnosis by 2–3 days. A special advantage directly identifies bacteria from the collected biological material, including semen [268] and urine [269]. Moreover, an expanding area of MALDI-TOF analyses represents a rapid detection of antibiotic resistance. Currently, β-lactamase activity is measurable by MALDI-TOF MS [270].
Several studies concern the MALDI-TOF MS bacterial identification of ejaculates originating from various species, including livestock animals and human samples [30,40,53,271,272]. A rapid identification demands a purification of the sample in advance. Nevertheless, isolation and culture of pure isolates on agar plates remain the most reliable way of bacterial identification by MALDI-TOF MS [267]. It is necessary to continuously evaluate the accuracy of MALDI-TOF to improve, revise, and add new spectra to the MALDI database. A previous report compared the reliability of identification of G+ isolates, stating that over 92% of identifications at the species level were consistent with 16 s rRNA sequencing. Conversely, less than 86% agreed with the case of the phenotypic method [273]. Even when very rare microorganisms were identified by both methods, MALDI-TOF and 16 s rRNA sequencing provided highly accurate results at the species level [274]. Similar to the previous reports, MALDI-TOF identification is considered an accurate method providing reproducible results for identifying nonfermenting bacteria [275].
6 Management of bacteriospermia: limitations and challenges
Reproductive biotechnologies and assisted reproductive technologies allow preservation of the genetic material of male individuals and exploit a maximum of its fertilization potential. These techniques come along with several advantages, including genetic improvement, implementation of reproductive procedures anytime and anywhere on the planet, and the prevention of disease transmission [276]. Conversely, just the process of sperm collection and cryopreservation may be a reason for an infectious disease spread in the recipient [268,277]. Therefore, antibacterial supplements must be added to semen extenders before the freezing procedures by law regardless of any effect on the postthaw sperm quality. Even if these are used in small amounts, unspecific consumption of antibiotics leads to antibiotic resistance [278]. Since one of the main sources of bacterial contamination is the preputium, strict hygiene standards may significantly help decrease the bacterial load in neat ejaculates. The semen collection equipment itself is another important source of potential bacterial contamination. Requiring high hygiene standards during collection, processing, and storage is the most effective way to protect spermatozoa from bacterial contaminants.
Trading animal semen has demanded regulations of antimicrobial supplements in semen extenders to avoid any potential transmission of infectious diseases. Therefore, the European Union and the European Council issued regulations that clarify the use of antibiotic cocktails in each insemination dose. According to the Council directive from June 26, 1990, no less than 500 IU/mL penicillin, 500 IU/mL streptomycin, 300 µg/mL spectinomycin, and 150 µg/mL lincomycin at a final concentration must be added to avoid the spread of mycoplasmas and leptospires. According to Spinosa et al. [279], antibacterial prevention frequently relies on substances that interrupt the synthesis of the cell wall leading to cell lysis and death (β-lactams) or which inhibit bacterial proteosynthesis (aminoglycosides, lincosamides, and macrolides). As reported by several studies [280,281,282], 500 µg/mL gentamycin, 300 µg/mL lincomycin, 100 µg/mL tylosin, and 600 µg/mL spectinomycin comprise the most recommended antimicrobial cocktail. However, these authors evaluated the subsequent bacterial susceptibility 10+ years ago.
A recent report [283] has stated that over 56% of all identified bacterial species in boar semen exhibited resistance to gentamycin, 24% were intermediate, and approximately every fifth bacterium was susceptible to gentamycin, lincomycin, penicillin, and neomycin. Faisal and Salman [284] observed the prevalence of E. coli, K. pneumoniae, and S. epidermidis in the semen of men seeking infertility treatment, where a multidrug resistance was determined. The bacteria showed the highest resistance to gentamycin, cefotaxime, ampicillin, and levofloxacin. Contrarily, the isolated bacteria were particularly susceptible to amikacin. Gentamycin was previously considered an ineffective antibiotic supplement in several studies [38,285,286]. Despite the resistance of bacteria to penicillin, streptomycin, and sulfanilamide, which has been observed decades ago [287], these antibiotics are still being used according to valid legislation. A recently published paper on microorganisms isolated from bull semen showed an alarming pattern of antibiotic resistance: 100% of isolates were resistant to penicillin, while most isolates were resistant to tylosin and lincomycin. Moreover, the legislatively required concentrations of antibiotics were insufficient in 60% of isolated microorganisms, while only in the case of 3.9% of isolates, these concentrations were defined as satisfactory [288]. Dalmutt et al. [289] characterized bacterial contaminants of boar semen and evaluated their antimicrobial susceptibility profiles. P. aeruginosa and P. mirabilis showed the highest antibiotic resistance rate. All P. mirabilis isolates were resistant to spectinomycin, lincomycin, florfenicol, and streptomycin. As such, insufficient legislative regulations together with irrational antibiotic overuse may lead to an even greater deterioration in antibiotic susceptibility and an increased multidrug resistance in a wider range of microorganisms.
Density gradient centrifugation represents a method based on cell sorting according to their density. The density of an intact mature sperm cell is above 1.10 g/mL, while damaged or immature spermatozoa have a density of 1.06–1.09 g/mL. Various concentrations of a colloid are layered on the top of each interphase, while the densest colloid solution is placed on the bottom of a conical test tube, more sparse colloids are placed onto itself, and the lowest colloid concentration is found on the top of the colloid column [290]. After layering the semen sample, low-speed centrifugation separates the seminal plasma, bacteria, leukocytes, immature cells, damaged spermatozoa, residues, and intact sperm cells according to their density and accumulates them at the interface of the individual interphases.
Previous studies have demonstrated the effective removal of bacteria and viruses from semen by several modifications of the density gradient centrifugation [278,291,292,293]. Particularly, in vitro fertilization practice has shown that density gradient centrifugation is an effective technique to diminish bacterial contamination [294]. Even our research team recently verified the effectiveness of bacterial removal from bovine semen (Figure 4). Besides improving the microbial status of semen, density gradient centrifugation also improves the quality of neat or thawed ejaculates of suboptimal quality. At the same time, no significant negative effects were recorded utilizing this method on normal spermatozoa. Therefore, colloid-based methods could reduce bacterial contamination without the necessity for antibiotics [295].
Efficacy of the density gradient centrifugation in the elimination of S. aureus from semen. Semen samples infected with S. aureus were seeded onto Tryptic soy agar. Samples placed on the left side were processed through density gradient centrifugation. No colony was grown on these plates, while the rest of the plates were overgrown by bacteria.
A recent report [39] has suggested that plant-based bioactive compounds may improve the fertility potential in semen samples contaminated with E. faecalis. Moreover, semen samples treated with penicillin, gentamycin, and kanamycin showed several deteriorated quality parameters compared to the experimental groups supplemented with quercetin, curcumin, and resveratrol. In particular, significant differences were observed when evaluating the sperm DNA fragmentation index. However, the potential beneficial effects of natural biomolecules on the maintenance of sperm DNA integrity were probably the result of their antioxidant properties rather than their antimicrobial activity.
Studies focused on the effects of pure bioactive substances on the microbial milieu provide promising results. However, more interesting data are oftentimes observed when evaluating the impact of plant extracts, thanks to their complex composition. Products of medicinal plants are widely used for their antioxidant effects or antibacterial properties. Schisandra chinensis extract ranging from 5 to 50 µg/mL exhibited outstanding protection to the sperm structures [296]. However, the minimal inhibition concentration required to inhibit the growth of 50% of the selected bacterial strains started at 64.2 µg/mL. Although the use of Schisandra extract maintains sperm quality on excellent levels, its use as an antimicrobial agent remains uncertain.
Elmi et al. [297] reported that Rosmarinus officinalis essential oil at 0.4 m/mL has exhibited antimicrobial activity comparable to ampicillin when evaluating the growth of E. coli, while spermatozoa quality stayed unchanged. Ros-Santaella and Pintus [298] recently reviewed plant extracts as alternative supplements for sperm preservation. Plant extracts are a relatively cheap source of beneficial substances. For example, the ginger extract at a concentration of 0.1 mg/mL has reduced the bacterial abundance in cryopreserved spermatophores, while no changes were observed in their structure or function [299]. Although several studies have published promising results on the antibacterial activity of natural bioactive compounds toward bacterial species isolated from semen, no report has revealed any pure compound or plant-based extract able to successfully diminish bacteria in semen while having beneficial effects on the sperm structure and behavior. High concentrations of bioactive substances needed to mitigate bacteriospermia on the one hand are too high to avoid a potentially negative impact on the seminal oxidative balance. In other words, effective antimicrobial concentrations of bioactive substances are too high not to act as prooxidants [300].
The use of nanoparticles may bring a new alternative to currently used antimicrobials. Boar ejaculates were previously investigated following treatment with Fe3O4 nanoparticles. After 30 min, the nanoparticles were removed, and the ejaculates were incubated for 48 h. It was revealed that the nanoparticles did not affect sperm motility, morphological characteristics, viability, membrane, and DNA integrity, while they provided a slight antimicrobial effect [301]. Silver–carbon nanoparticles were tested against bacteriospermia of fresh bovine semen. Several bacterial species, including E. coli, S. aureus, and P. aeruginosa, were isolated, and minimum inhibitory and bactericidal concentrations were analyzed. A 3.125 µg/mL concentration exhibited bactericidal activity in S. aureus and P. aeruginosa. The growth of E. coli was inhibited by a 12.5 µg/mL concentration. The authors have revealed that concentrations ≤30 µg/mL did not affect the sperm parameters, including motility, viability, acrosomal status, or morphology. Therefore, nanoparticles may represent a favorable option in the search for potential antimicrobial substances for stored semen [302].
7 Conclusions
Evidence collected in this review strongly indicates that the presence of bacteria in semen may negatively impact the sperm structure and function, leading to subfertility or even infertility. Nevertheless, the molecular mechanisms by which bacteriospermia affects male reproduction are complex and intricate. Besides a direct bacterial action on the male gamete, inflammation and oxidative stress may play pivotal roles in the pathology of bacteriospermia. Nevertheless, specific interactions of the reproductive tract and immune system during bacterial infection need further elucidation. Follow-up studies on the intricate network of relationships on a biochemical, molecular, immunological, and oxidative level may provide new directions to the development of novel diagnostic tools and biomarkers for a fast and reliable diagnosis of bacteriospermia as well as advances in appropriate strategies to prevent or manage bacterial contamination of semen in the future.
Acknowledgment
We wish to thank the CeRA Team of Excellence for their support.
-
Funding information: Data collection for this review was supported by the Cultural and Educational Grant Agency of the Ministry of Education, Science, Research and Sport of the Slovak Republic (KEGA 008SPU-4/2021), the Scientific Grant Agency of the Ministry of Education, Science, Research and Sport of the Slovak Republic (VEGA 1/0239/20), and the Slovak Research and Development Agency (APVV-21-0095).
-
Author contributions: All authors participated in the preparation and review of the manuscript. E.T. and M.Ď. designed the layout and sections of the review, performed the literature search, and wrote the original draft of the manuscript. F.B. designed the figures. N.L. acted in a supervising capacity and performed the data search in scientific databases. All authors have read and approved the final version of the manuscript.
-
Conflict of interest: Authors state no conflict of interest.
-
Data availability statement: Data sharing is not applicable to this article as no datasets were generated or analyzed during the current study.
References
[1] Centola GM, Blanchard A, Demick J, Li S, Eisenberg ML. Decline in sperm count and motility in young adult men from 2003 to 2013: observations from a U.S. sperm bank. Andrology. 2016;4(2):270–6.10.1111/andr.12149Search in Google Scholar PubMed
[2] Sengupta P, Dutta S, Krajewska-Kulak E. The disappearing sperms: analysis of reports published between 1980 and 2015. Am J Mens Health. 2017;11(4):1279–304.10.1177/1557988316643383Search in Google Scholar PubMed PubMed Central
[3] Ohlsson Wijk S, Andersson G. Disentangling the swedish fertility decline of the 2010s. Stockholm Res Rep Demograph Preprint. 2022, Epub 2022 January 24.10.4054/DemRes.2022.47.12Search in Google Scholar
[4] Carlsen E, Swan SH, Petersen JH, Skakkebaek NE. Longitudinal changes in semen parameters in young danish men from the copenhagen area. Hum Reprod. 2005;20(4):942–9.10.1093/humrep/deh704Search in Google Scholar PubMed
[5] Lackner J, Schatzl G, Waldhör T, Resch K, Kratzik C, Marberger M. Constant decline in sperm concentration in infertile males in an urban population: experience over 18 years. Fertil Steril. 2005;84(6):1657–61.10.1016/j.fertnstert.2005.05.049Search in Google Scholar PubMed
[6] Różański W, Szymczak W, Wójt M, Sobakiewicz S, Lipiński M, Marchlewska K, et al. Semen quality in men from subfertile couples from the region of Łódź (Poland) according to the new reference values recommended by WHO 2010. Cent European J Urol. 2011;64(1):34–8.10.5173/ceju.2011.01.art7Search in Google Scholar PubMed PubMed Central
[7] Rolland M, Le Moal J, Wagner V, Royère D, De Mouzon J. Decline in semen concentration and morpholoy in a sample of 26,609 men close to general population between 1989 and 2005 in France. Hum Reprod. 2013;28(2):462–70.10.1093/humrep/des415Search in Google Scholar PubMed PubMed Central
[8] Sengupta P, Borges E Jr, Dutta S, Krajewska-Kulak E. Decline in sperm count in european men during the past 50 years. Hum Exp Toxicol. 2018;37(3):247–55.10.1177/0960327117703690Search in Google Scholar PubMed
[9] De Sangre P. Patterns of fertility in Italy and factors of its decline. Genus. 2000;56:19–54.Search in Google Scholar
[10] Sengupta P, Nwagha U, Dutta S, Krajewska-Kulak E, Izuka E. Evidence for decreasing sperm count in African population from 1965 to 2015. Afr Health Sci. 2017;17(2):418–27.10.4314/ahs.v17i2.16Search in Google Scholar PubMed PubMed Central
[11] Yuan HF, Shangguan HF, Zheng Y, Meng TQ, Xiong CL, Guan HT. Decline in semen concentration of healthy Chinese adults: evidence from 9357 participants from 2010 to 2015. Asian J Androl. 2018;20(4):379–84.10.4103/aja.aja_80_17Search in Google Scholar PubMed PubMed Central
[12] Mascarenhas MN, Flaxman SR, Boerma T, Vanderpoel S, Stevens GA. National, regional, and global trends in infertility prevalence since 1990: a systematic analysis of 277 health surveys. PLoS Med. 2012;9:e1001356.10.1371/journal.pmed.1001356Search in Google Scholar
[13] Kumaresan A, Das Gupta M, Datta TK, Morrell JM. Sperm DNA integrity and male fertility in farm animals: A review. Front Vet Sci. 2020;7:321.10.3389/fvets.2020.00321Search in Google Scholar
[14] Agarwal A, Baskaran S, Parekh N, Cho CL, Henkel R, Vij S, et al. Male infertility. Lancet. 2021;397(10271):319–33.10.1002/9781444323146.ch16Search in Google Scholar
[15] Agarwal A, Mulgund A, Hamada A, Chyatte MR. A unique view on male infertility around the globe. Reprod Biol Endocrinol. 2015;13:37.10.1186/s12958-015-0032-1Search in Google Scholar
[16] Dobson H, Walker SL, Morris MJ, Routly JE, Smith RF. Why is it getting more difficult to successfully artificially inseminate dairy cows? Animal. 2008;2:1104–11.10.1017/S175173110800236XSearch in Google Scholar
[17] Lucy MC. Reproductive loss in high-producing dairy cattle: Where will it end? J Dairy Sci. 2001;84:1277–93.10.3168/jds.S0022-0302(01)70158-0Search in Google Scholar
[18] Slade P, O’Neill C, Simpson AJ, Lashen H. The relationship between perceived stigma, disclosure patterns, support and distress in new attendees at an infertility clinic. Hum Reprod. 2007;22:2309–17.10.1093/humrep/dem115Search in Google Scholar PubMed
[19] Wu AK, Elliott P, Katz PP, Smith JF. Time costs of fertility care: the hidden hardship of building a family. Fertil Steril. 2013;99:2025–30.10.1016/j.fertnstert.2013.01.145Search in Google Scholar PubMed PubMed Central
[20] Kuroda S, Usui K, Sanjo H, Takeshima T, Kawahara T, Uemura H, et al. Genetic disorders and male infertility. Reprod Med Biol. 2020;19(4):314–22.10.1002/rmb2.12336Search in Google Scholar PubMed PubMed Central
[21] Punab M, Poolamets O, Paju P, Vihljajev V, Pomm K, Ladva R, et al. Causes of male infertility: a 9-year prospective monocentre study on 1737 patients with reduced total sperm counts. Hum Reprod. 2017;32(1):18–31.10.1093/humrep/dew284Search in Google Scholar PubMed PubMed Central
[22] Kothandaraman N, Agarwal A, Abu-Elmagd M, Al-Qahtani MH. Pathogenic landscape of idiopathic male infertility: new insight towards its regulatory networks. NPJ Genom Med. 2016;1:16023.10.1038/npjgenmed.2016.23Search in Google Scholar PubMed PubMed Central
[23] Rosenthal L. Agglutinating properties of Escherichia coli: agglutination of erythroces, leucocytes, thrombocytes, spermatozoa, spores of molds, and pollen by strains of E. coli. J Bacteriol. 1943;45(6):545–50.10.1128/jb.45.6.545-550.1943Search in Google Scholar PubMed PubMed Central
[24] Hutchings LM, Andrews FN. Isolation of Brucella suis from boar’s semen. J Bacteriol. 1945;50:715.Search in Google Scholar
[25] Al-Damoshi HO, Naher S. Al-Charrakh A. Bacteriospermia. 1st edn. Saarbrucken: LAP Lambert Akademikverlag; 2009.Search in Google Scholar
[26] Rusz A, Pilatz A, Wagenlehner F, Linn T, Diemer T, Schuppe HC, et al. Influence of urogenital infections and inflammation on semen quality and male fertility. World J Urol. 2012;30(1):23–30.10.1007/s00345-011-0726-8Search in Google Scholar PubMed
[27] Pergialiotis V, Karampetsou N, Perrea DN, Konstantopoulos P, Daskalakis G. The impact of bacteriospermia on semen parameters: A meta-analysis. J Family Reprod Health. 2018;12(2):73–83.Search in Google Scholar
[28] Fraczek M, Kurpisz M. Mechanisms of the harmful effects of bacterial semen infection on ejaculated human spermatozoa: potential inflammatory markers in semen. Folia Histochem Cytobiol. 2015;53(3):201–17.10.5603/fhc.a2015.0019Search in Google Scholar PubMed
[29] Domes T, Lo KC, Grober ED, Mullen JB, Mazzulli T, Jarvi K. The incidence and effect of bacteriospermia and elevated seminal leukocytes on semen parameters. Fertil Steril. 2012;97(5):1050–5.10.1016/j.fertnstert.2012.01.124Search in Google Scholar PubMed
[30] Ďuračka M, Belić L, Tokárová K, Žiarovská J, Kačániová M, Lukáč N, et al. Bacterial communities in bovine ejaculates and their impact on the semen quality. Syst Biol Reprod Med. 2021;67(6):438–49.10.1080/19396368.2021.1958028Search in Google Scholar PubMed
[31] Tvrdá E, Kačániová M, Baláži A, Vašíček J, Vozaf J, Jurčík R, et al. The impact of bacteriocenoses on sperm vitality, immunological and oxidative characteristics of ram ejaculates: does the breed play a role? Animals (Basel). 2021;12(1):54.10.3390/ani12010054Search in Google Scholar PubMed PubMed Central
[32] Tvrdá E, Bučko O, Rojková K, Ďuračka M, Kunová S, Kováč J, et al. The efficiency of selected extenders against bacterial contamination of boar semen in a swine breeding facility in Western Slovakia. Animals (Basel). 2021;11(11):3320.10.3390/ani11113320Search in Google Scholar PubMed PubMed Central
[33] Rana N, Vaid RK, Phulia SK, Singh P. Assessment of bacterial diversity in fresh bubaline semen. Indian J Anim Sci. 2012;82(6):596–8.Search in Google Scholar
[34] Sepúlveda Muela L. Bacteriospermia and porcine reproduction: effects on sperm quality and fertility potential of boar spermatozoa [dissertation]. Girona: Universitat de Girona; 2016.Search in Google Scholar
[35] Otter A. Bacterial isolates from the semen of rams with suspected infertility. Vet Rec. 2008;162(19):623–4.10.1136/vr.162.19.623Search in Google Scholar PubMed
[36] Medo J, Žiarovská J, Ďuračka M, Tvrdá E, Baňas Š, Gábor M, et al. Core microbiome of Slovak holstein friesian breeding bulls’ semen. Animals (Basel). 2021;11(11):3331.10.3390/ani11113331Search in Google Scholar PubMed PubMed Central
[37] Cojkic A, Niazi A, Guo Y, Hallap T, Padrik P, Morrell JM. Identification of bull semen microbiome by 16S sequencing and possible relationships with fertility. Microorganisms. 2021;9:2431.10.3390/microorganisms9122431Search in Google Scholar PubMed PubMed Central
[38] Gączarzewicz D, Udała J, Piasecka M, Błaszczyk B, Stankiewicz T. Bacterial contamination of boar semen and its relationship to sperm quality preserved in commercial extender containing gentamicin sulfate. Pol J Vet Sci. 2016;19(3):451–9.10.1515/pjvs-2016-0057Search in Google Scholar PubMed
[39] Duracka M, Lukac N, Kacaniova M, Kantor A, Hleba L, Ondruska L, et al. Antibiotics versus natural biomolecules: the case of in vitro induced bacteriospermia by Enterococcus faecalis in rabbit semen. Molecules. 2019;24(23):4329.10.3390/molecules24234329Search in Google Scholar PubMed PubMed Central
[40] Lenický M, Slanina T, Kačániová M, Galovičová L, Petrovičová M, Ďuračka M, et al. Identification of bacterial profiles and their interactions with selected quality, oxidative, and immunological parameters of turkey semen. Animals (Basel). 2021;11(6):1771.10.3390/ani11061771Search in Google Scholar PubMed PubMed Central
[41] Quiñones-Pérez C, Martínez A, Crespo F, Vega-Pla JL. Comparative semen microbiota composition of a stallion in a Taylorella equigenitalis carrier and non-carrier state. Animals (Basel). 2020;10(5):868.10.3390/ani10050868Search in Google Scholar PubMed PubMed Central
[42] Al-Kass Z, Eriksson E, Bagge E, Wallgren M, Morrell JM. Bacteria detected in the genital tract, semen or pre-ejaculatory fluid of Swedish stallions from 2007 to 2017. Acta Vet Scand. 2019;61(1):25.10.1186/s13028-019-0459-zSearch in Google Scholar PubMed PubMed Central
[43] Baud D, Pattaroni C, Vulliemoz N, Castella V, Marsland BJ, Stojanov M. Sperm microbiota and its impact on semen parameters. Front Microbiol. 2019;10:234.10.3389/fmicb.2019.00234Search in Google Scholar PubMed PubMed Central
[44] Bussalleu E, Yeste M, Sepúlveda L, Torner E, Pinart E, Bonet S. Effects of different concentrations of enterotoxigenic and verotoxigenic E. coli on boar sperm quality. Anim Reprod Sci. 2011;127(3–4):176–82.10.1016/j.anireprosci.2011.07.018Search in Google Scholar PubMed
[45] Prieto-Martínez N, Bussalleu E, Garcia-Bonavila E, Bonet S, Yeste M. Effects of Enterobacter cloacae on boar sperm quality during liquid storage at 17°C. Anim Reprod Sci. 2014;148(1–2):72–82.10.1016/j.anireprosci.2014.05.008Search in Google Scholar PubMed
[46] Rennemeier C, Frambach T, Hennicke F, Dietl J, Staib P. Microbial quorum-sensing molecules induce acrosome loss and cell death in human spermatozoa. Infect Immun. 2009;77(11):4990–7.10.1128/IAI.00586-09Search in Google Scholar PubMed PubMed Central
[47] Fraczek M, Piasecka M, Gaczarzewicz D, Szumala-Kakol A, Kazienko A, Lenart S, et al. Membrane stability and mitochondrial activity of human-ejaculated spermatozoa during in vitro experimental infection with Escherichia coli, Staphylococcus haemolyticus and Bacteroides ureolyticus. Andrologia. 2012;44(5):315–29.10.1111/j.1439-0272.2012.01283.xSearch in Google Scholar
[48] Fraczek M, Hryhorowicz M, Gaczarzewicz D, Szumala-Kakol A, Kolanowski TJ, Beutin L, et al. Can apoptosis and necrosis coexist in ejaculated human spermatozoa during in vitro semen bacterial infection? J Assist Reprod Genet. 2015;32(5):771–9.10.1007/s10815-015-0462-xSearch in Google Scholar
[49] Ďuračka M, Husarčíková K, Jančov M, Galovičová L, Kačániová M, Lukáč N, et al. Staphylococcus-induced bacteriospermia in vitro: consequences on the bovine spermatozoa quality, extracellular calcium and magnesium content. Animals (Basel). 2021;11(11):3309.10.3390/ani11113309Search in Google Scholar
[50] Marchiani S, Baccani I, Tamburrino L, Mattiuz G, Nicolò S, Bonaiuto C, et al. Effects of common Gram-negative pathogens causing male genitourinary-tract infections on human sperm functions. Sci Rep. 2021;11(1):19177.10.1038/s41598-021-98710-5Search in Google Scholar
[51] Prabha V, Kaur S. Isolation and purification of sperm immobilizing/agglutinating factors from bacteria and their corresponding receptors from human spermatozoa. In: Calderon LdA, editor. Chromatography - the most versatile method of chemical analysis. London: IntechOpen; 2012. p. 295–310.10.5772/48594Search in Google Scholar
[52] Fijak M, Pilatz A, Hedger MP, Nicolas N, Bhushan S, Michel V, et al. Infectious, inflammatory and ‘autoimmune’ male factor infertility: how do rodent models inform clinical practice? Hum Reprod Update. 2018;24(4):416–41.10.1093/humupd/dmy009Search in Google Scholar
[53] Ďuračka M, Kováčik A, Kačániová M, Lukáč N, Tvrdá E. Bacteria may deteriorate progressive motility of bovine spermatozoa and biochemical parameters of seminal plasma. J Microbiol Biotech Food Sci. 2020;9(4):844–7.10.15414/jmbfs.2020.9.4.844-847Search in Google Scholar
[54] Purdy PH, Tharp N, Stewart T, Spiller SF, Blackburn HD. Implications of the pH and temperature of diluted, cooled boar semen on fresh and frozen-thawed sperm motility characteristics. Theriogenology. 2010;74(7):1304–10.10.1016/j.theriogenology.2010.04.030Search in Google Scholar
[55] Zhang F, Dai J, Chen T. Role of Lactobacillus in female infertility via modulating sperm agglutination and immobilization. Front Cell Infect Microbiol. 2021;10:620529.10.3389/fcimb.2020.620529Search in Google Scholar
[56] Wolff H, Panhans A, Stolz W, Meurer M. Adherence of Escherichia coli to sperm: a mannose mediated phenomenon leading to agglutination of sperm and E. coli. Fertil Steril. 1993;60(1):154–8.10.1016/S0015-0282(16)56054-3Search in Google Scholar
[57] Shang Y, Liu C, Cui D, Han G, Yi S. The effect of chronic bacterial prostatitis on semen quality in adult men: a meta-analysis of case-control studies. Sci Rep. 2014;4:7233.10.1038/srep07233Search in Google Scholar PubMed PubMed Central
[58] Wang S, Zhang K, Yao Y, Li J, Deng S. Bacterial infections affect male fertility: a focus on the oxidative stress-autophagy axis. Front Cell Dev Biol. 2021;9:727812.10.3389/fcell.2021.727812Search in Google Scholar PubMed PubMed Central
[59] Stones DH, Krachler AM. Against the tide: the role of bacterial adhesion in host colonization. Biochem Soc Trans. 2016;44(6):1571–80.10.1042/BST20160186Search in Google Scholar PubMed PubMed Central
[60] Wang H, Chen T, Chen Y, Luo T, Tan B, Chen H, et al. Evaluation of the inhibitory effects of vaginal microorganisms on sperm motility in vitro. Exp Ther Med. 2020;19(1):535–44.10.3892/etm.2019.8237Search in Google Scholar PubMed PubMed Central
[61] Monga M, Roberts JA. Spermagglutination by bacteria: receptor-specific interactions. J Androl. 1994;15:151–6.10.1002/j.1939-4640.1994.tb00423.xSearch in Google Scholar
[62] Benoff S, Cooper GW, Centola GM, Jacob A, Hershlag A, Hurley IR. Metal ions and human sperm mannose receptors. Andrologia. 2000;32(4–5):317–29.10.1046/j.1439-0272.2000.00401.xSearch in Google Scholar PubMed
[63] Wright KJ, Seed PC, Hultgren SJ. Development of intracellular bacterial communities of uropathogenic Escherichia coli depends on type 1 pili. Cell Microbiol. 2007;9(9):2230–41.10.1111/j.1462-5822.2007.00952.xSearch in Google Scholar PubMed
[64] Agarwal J, Srivastava S, Singh M. Pathogenomics of uropathogenic Escherichia coli. Indian J Med Microbiol. 2012;30:141–9.10.4103/0255-0857.96657Search in Google Scholar PubMed
[65] Mashaly M, Masallat DT, Elkholy AA, Abdel-Hamid IA, Mostafa T. Seminal Corynebacterium strains in infertile men with and without leucocytospermia. Andrologia. 2016;48(3):355–9.10.1111/and.12457Search in Google Scholar PubMed
[66] Kaur S, Prabha V, Sarwal A. Receptor mediated agglutination of human spermatozoa by spermagglutinating factor isolated from Staphylococcus aureus. J Urol. 2010;184(6):2586–90.10.1016/j.juro.2010.07.031Search in Google Scholar PubMed
[67] Barbu EM, Mackenzie C, Foster TJ, Höök M. SdrC induces staphylococcal biofilm formation through a homophilic interaction. Mol Microbiol. 2014;94(1):172–85.10.1111/mmi.12750Search in Google Scholar PubMed PubMed Central
[68] Henderson B, Martin A. Bacterial virulence in the moonlight: multitasking bacterial moonlighting proteins are virulence determinants in infectious disease. Infect Immun. 2011;79(9):3476–91.10.1128/IAI.00179-11Search in Google Scholar
[69] Hori K, Matsumoto S. Bacterial adhesion: From mechanism to control. Biochem Eng J. 2010;48(3):424–34.10.1016/j.bej.2009.11.014Search in Google Scholar
[70] Katsikogianni M, Missirlis YF. Concise review of mechanisms of bacterial adhesion to biomaterials and of techniques used in estimating bacteria-material interactions. Eur Cell Mater. 2004;8:37–57.10.22203/eCM.v008a05Search in Google Scholar
[71] Allow AK, Sadek SM, Abdulmogny A, Maryam B, Alaw BA. Sperm agglutination, sperm shaky head movement and sperm-cervical interaction tests could be enough for diagnosis of immunological infertility? J Gynecol Women’s Health. 2017;3(1):1–6.10.19080/JGWH.2017.03.555603Search in Google Scholar
[72] Rabin N, Zheng Y, Opoku-Temeng C, Du Y, Bonsu E, Sintim HO. Biofilm formation mechanisms and targets for developing antibiofilm agents. Future Med Chem. 2015;7(4):493–512.10.4155/fmc.15.6Search in Google Scholar
[73] Kaur K, Kaur S, Rishi P, Singh SK, Prabha V. Evidence for the occurrence of receptor in sperm for spermagglutinating factor isolated from Escherichia coli. Gynecol Endocrinol. 2012;34:207–9.Search in Google Scholar
[74] Kaur K, Prabha V. Impairment by sperm agglutinating factor isolated from Escherichia coli: receptor specific interactions. Biomed Res Int. 2013;2013:548497.10.1155/2013/548497Search in Google Scholar
[75] Pant NC, Singh R, Gupta V, Chauhan A, Mavuduru R, Prabha V, et al. Contraceptive efficacy of sperm agglutinating factor from Staphylococcus warneri, isolated from the cervix of a woman with inexplicable infertility. Reprod Biol Endocrinol. 2019;17(1):85.10.1186/s12958-019-0531-6Search in Google Scholar
[76] Ohri M, Prabha V. Isolation of a sperm-agglutinating factor from Staphylococcus aureus isolated from a woman with unexplained infertility. Fertil Steril. 2005;84(5):1539–41.10.1016/j.fertnstert.2005.05.030Search in Google Scholar
[77] Paulson JD, Polakoski KL. Isolation of a spermatozoal immobilization factor from Escherichia coli filtrates. Fertil Steril. 1977;28(2):182–5.10.1016/S0015-0282(16)42380-0Search in Google Scholar
[78] Prabha V, Sandhu R, Kaur S, Kaur K, Sarwal A, Mavuduru RS, et al. Mechanism of sperm immobilization by Escherichia coli. Adv Urol. 2010;2010:240268.10.1155/2010/240268Search in Google Scholar PubMed PubMed Central
[79] Vander H, Gupta S, Kaur S, Kaur K, Prabha V. Characterization of sperm immobilization factor from Escherichia coli and its receptor to study the underlying mechanism of sperm immobilization. Am J Biomed Sci. 2013;5(1):25–33.10.5099/aj130100025Search in Google Scholar
[80] Prabha V, Gupta T, Kaur S, Kaur N, Kala S, Singh A. Isolation of a spermatozoal immobilization factor from Staphylococcus aureus filtrates. Can J Microbiol. 2009;55(7):874–8.10.1139/W09-032Search in Google Scholar
[81] Sellami H, Znazen A, Sellami A, Mnif H, Louati N, Ben Zarrouk S, et al. Molecular detection of Chlamydia trachomatis and other sexually transmitted bacteria in semen of male partners of infertile couples in Tunisia: the effect on semen parameters and spermatozoa apoptosis markers. PLoS One. 2014;9(7):e98903.10.1371/journal.pone.0098903Search in Google Scholar PubMed PubMed Central
[82] Berger GK, Smith-Harrison LI, Sandlow JI. Sperm agglutination: Prevalence and contributory factors. Andrologia. 2019;51(5):e13254.10.1111/and.13254Search in Google Scholar PubMed
[83] Raetz CR, Whitfield C. Lipopolysaccharide endotoxins. Annu Rev Biochem. 2002;71:635–700.10.1146/annurev.biochem.71.110601.135414Search in Google Scholar PubMed PubMed Central
[84] Gioannini TL, Weiss JP. Regulation of interactions of Gram-negative bacterial endotoxins with mammalian cells. Immunol Res. 2007;39(1–3):249–60.10.1007/s12026-007-0069-0Search in Google Scholar PubMed
[85] Aly HA, El-Beshbishy HA, Banjar ZM. Mitochondrial dysfunction induced impairment of spermatogenesis in LPS-treated rats: modulatory role of lycopene. Eur J Pharmacol. 2012;677(1–3):31–8.10.1016/j.ejphar.2011.12.027Search in Google Scholar PubMed
[86] Zhang X, Shi K, Li Y, Zhang H, Hao J. Lipopolysaccharide inhibits the self-renewal of spermatogonial stem cells in vitro via downregulation of GDNF expression in Sertoli cells. Reprod Toxicol. 2014;45:87–93.10.1016/j.reprotox.2014.01.009Search in Google Scholar PubMed
[87] Brecchia G, Cardinali R, Mourvaki E, Collodel G, Moretti E, Dal Bosco, et al. Short- and long-term effects of lipopolysaccharide-induced inflammation on rabbit sperm quality. Anim Reprod Sci. 2010;118:310–6.10.1016/j.anireprosci.2009.06.016Search in Google Scholar PubMed
[88] Dey S, Roy D, Majumder GC, Bhattacharyya D. Extracellular regulation of sperm transmembrane adenylyl cyclase by a forward motility stimulating protein. PLoS One. 2014;9(10):e110669.10.1371/journal.pone.0110669Search in Google Scholar PubMed PubMed Central
[89] Jansen V, Alvarez L, Balbach M, Strünker T, Hegemann P, Kaupp UB, et al. Controlling fertilization and cAMP signaling in sperm by optogenetics. Elife. 2015;4:e05161.10.7554/eLife.05161Search in Google Scholar
[90] Li Z, Zhang D, He Y, Ding Z, Mao F, Luo T, et al. Lipopolysaccharide compromises human sperm function by reducing intracellular cAMP. Tohoku J Exp Med. 2016;238(2):105–2.10.1620/tjem.238.105Search in Google Scholar
[91] Ristow LC, Welch RA. Hemolysin of uropathogenic Escherichia coli: A cloak or a dagger? Biochim Biophys Acta. 2016;1858(3):538–45.10.1016/j.bbamem.2015.08.015Search in Google Scholar
[92] Bhakdi S, Mackman N, Nicaud JM, Holland IB. Escherichia coli hemolysin may damage target cell membranes by generating transmembrane pores. Infect Immun. 1986;52(1):63–9.10.1128/iai.52.1.63-69.1986Search in Google Scholar
[93] Menestrina G, Mackman N, Holland IB, Bhakdi S. Escherichia coli haemolysin forms voltage-dependent ion channels in lipid membranes. Biochim Biophys Acta. 1987;905(1):109–17.10.1016/0005-2736(87)90014-9Search in Google Scholar
[94] Menestrina G, Ropele M. Voltage-dependent gating properties of the channel formed by E. coli hemolysin in planar lipid membranes. Biosci Rep. 1989;9(4):465–73.10.1007/BF01117049Search in Google Scholar PubMed
[95] Boguen R, Treulen F, Uribe P, Villegas JV. Ability of Escherichia coli to produce hemolysis leads to a greater pathogenic effect on human sperm. Fertil Steril. 2015;103(5):1155–61.10.1016/j.fertnstert.2015.01.044Search in Google Scholar PubMed
[96] Qiang H, Jiang MS, Lin JY, He WM. Influence of enterococci on human sperm membrane in vitro. Asian J Androl. 2007;9(1):77–81.10.1111/j.1745-7262.2007.00219.xSearch in Google Scholar PubMed
[97] Williams P. Quorum sensing, communication and cross-kingdom signaling in the bacterial world. Microbiology (Reading). 2007;153(Pt 12):3923–38.10.1099/mic.0.2007/012856-0Search in Google Scholar PubMed
[98] Khodamoradi K, Kuchakulla M, Narasimman M, Khosravizadeh Z, Ali A, Brackett N, et al. Laboratory and clinical management of leukocytospermia and hematospermia: a review. Ther Adv Reprod Health. 2020;14:2633494120922511.10.1177/2633494120922511Search in Google Scholar PubMed PubMed Central
[99] Sanocka D, Fraczek M, Jedrzejczak P, Szumała-Kakol A, Kurpisz M. Male genital tract infection: an influence of leukocytes and bacteria on semen. J Reprod Immunol. 2004;62:111–24.10.1016/j.jri.2003.10.005Search in Google Scholar PubMed
[100] Ventimiglia E, Capogrosso P, Boeri L, Cazzaniga W, Matloob R, Pozzi E, et al. Leukocytospermia is not an informative predictor of positive semen culture in infertile men: results from a validation study of available guidelines. Hum Reprod Open. 2020;2020(3):hoaa039.10.1093/hropen/hoaa039Search in Google Scholar PubMed PubMed Central
[101] Moubasher A, Sayed H, Mosaad E, Mahmoud A, Farag F, Taha EA. Impact of leukocytospermia on sperm dynamic motility parameters, DNA and chromosomal integrity. Cent European J Urol. 2018;71(4):470–5.10.5173/ceju.2018.1724Search in Google Scholar
[102] Lackner JE, Märk I, Sator K, Huber J, Sator M. Effect of leukocytospermia on fertilization and pregnancy rates of artificial reproductive technologies. Fertil Steril. 2008;90(3):869–71.10.1016/j.fertnstert.2007.07.1310Search in Google Scholar PubMed
[103] Cavagna M, Oliveira JB, Petersen CG, Mauri AL, Silva LF, Massaro FC, et al. The influence of leukocytospermia on the outcomes of assisted reproductive technology. Reprod Biol Endocrinol. 2012;10:44.10.1186/1477-7827-10-44Search in Google Scholar PubMed PubMed Central
[104] Henkel RR. Leukocytes and oxidative stress: dilemma for sperm function and male fertility. Asian J Androl. 2011;13(1):43–52.10.1038/aja.2010.76Search in Google Scholar PubMed PubMed Central
[105] Piasecka M, Fraczek M, Gaczarzewicz D, Gill K, Szumala-Kakol A, Kazienko A, et al. Novel morphological findings of human sperm removal by leukocytes in in vivo and in vitro conditions: preliminary study. Am J Reprod Immunol. 2014;72(4):348–58.10.1111/aji.12284Search in Google Scholar PubMed
[106] Prabha V, Chaudhary N, Kaur S. Molecular mimicry between spermatozoa and bacteria. J Urol. 2011;186(6):2442–7.10.1016/j.juro.2011.07.084Search in Google Scholar PubMed
[107] Tsang RS, Chan KH, Chau PY, Wan KC, Ng MH, Schlecht S. A murine monoclonal antibody specific for the outer core oligosaccharide of Salmonella lipopolysaccharide. Infect Immun. 1987;55(1):211–6.10.1128/iai.55.1.211-216.1987Search in Google Scholar PubMed PubMed Central
[108] Martínez-Prado E, Camejo Bermúdez MI. Expression of IL-6, IL-8, TNF-alpha, IL-10, HSP-60, anti-HSP-60 antibodies, and anti-sperm antibodies, in semen of men with leukocytes and/or bacteria. Am J Reprod Immunol. 2010;63(3):233–43.10.1111/j.1600-0897.2009.00786.xSearch in Google Scholar PubMed
[109] Naaby-Hansen S, Herr JC. Heat shock proteins on the human sperm surface. J Reprod Immunol. 2010;84(1):32–40.10.1016/j.jri.2009.09.006Search in Google Scholar PubMed PubMed Central
[110] Silva AF, Ramalho-Santos J, Amaral S. The impact of antisperm antibodies on human male reproductive function: an update. Reproduction. 2021;162(4):R55–71.10.1530/REP-21-0123Search in Google Scholar
[111] Jones DB, Coulson AF, Duff GW. Sequence homologies between hsp60 and autoantigens. Immunol Today. 1993;14(3):115–8.10.1016/0167-5699(93)90210-CSearch in Google Scholar
[112] Eggert-Kruse W, Batschulat K, Demirakca T, Strowitzki T. Male immunity to the chlamydial 60 kDa heat shock protein (HSP 60) - associated with semen quality? Andrologia. 2015;47(1):66–76.10.1111/and.12224Search in Google Scholar PubMed
[113] Perdichizzi A, Nicoletti F, La Vignera S, Barone N, D'agata R, Vicari E, et al. Effects of tumour necrosis factor-alpha on human sperm motility and apoptosis. J Clin Immunol. 2007;27:152–62.10.1007/s10875-007-9071-5Search in Google Scholar PubMed
[114] Barroso G, Morshedi M, Oehninger S. Analysis of DNA fragmentation, plasma membrane translocation of phosphatidylserine and oxidative stress in human spermatozoa. Hum Reprod. 2000;15:1338–44.10.1093/humrep/15.6.1338Search in Google Scholar PubMed
[115] Dziadecki W, Celińska A, Fracki S, Bablok L, Barcz E. Interleukin 1b and interleukin 18 and their connection with leukocytospermia in human semen. Centr Eur J Immunol. 2010;35:157–61.Search in Google Scholar
[116] Koçak I, Yenisey C, Dündar M, Okyay P, Serter M. Relationship between seminal plasma interleukin-6 and tumor necrosis factor alpha levels with semen parameters in fertile and infertile men. Urol Res. 2002;30:263–7.10.1007/s00240-002-0269-ySearch in Google Scholar PubMed
[117] Lotti F, Maggi M. Interleukin 8 and the male genital tract. J Reprod Immunol. 2013;100:54–65.10.1016/j.jri.2013.02.004Search in Google Scholar PubMed
[118] Fraczek M, Szumala-Kakol A, Dworacki G, Sanocka D, Kurpisz M. In vitro reconstruction of inflammatory reaction in human semen: effect on sperm DNA fragmentation. J Reprod Immunol. 2013;100:76–85.10.1016/j.jri.2013.09.005Search in Google Scholar PubMed
[119] Qian L, Zhou Y, Du C, Wen J, Teng S, Teng Z. IL-18 levels in the semen of male infertility: semen analysis. Int J Biol Macromol. 2014;64:190–2.10.1016/j.ijbiomac.2013.12.005Search in Google Scholar PubMed
[120] Brinkmann V, Zychlinsky A. Neutrophil extracellular traps: is immunity the second function of chromatin? J Cell Biol. 2012;198:773–83.10.1083/jcb.201203170Search in Google Scholar PubMed PubMed Central
[121] Schulz M, Zambrano F, Schuppe HC, Wagenlehner F, Taubert A, Gaertner U, et al. Monocyte-derived extracellular trap (MET) formation induces aggregation and affects motility of human spermatozoa in vitro. Syst Biol Reprod Med. 2019;65(5):357–66.10.1080/19396368.2019.1624873Search in Google Scholar PubMed
[122] Goldmann O, Medina E. The expanding world of extracellular traps: not only neutrophils but much more. Front Immunol. 2013;3:420.10.3389/fimmu.2012.00420Search in Google Scholar PubMed PubMed Central
[123] Manda A, Pruchniak MP, Araźna M, Demkow UA. Neutrophil extracellular traps in physiology and pathology. Cent Eur J Immunol. 2014;39(1):116–21.10.5114/ceji.2014.42136Search in Google Scholar PubMed PubMed Central
[124] Zambrano F, Carrau T, Gärtner U, Seipp A, Taubert A, Felmer R, et al. Leukocytes coincubated with human sperm trigger classic neutrophil extracellular traps formation, reducing sperm motility. Fertil Steril. 2016;106:1053–60.10.1016/j.fertnstert.2016.06.005Search in Google Scholar PubMed
[125] Tvrdá E, Massanyi P, Lukáč N. Physiological and pathological roles of free radicals in male reproduction. In: Meccariello R, Chianese R, editors. Spermatozoa-facts and perspectives. London: IntechOpen; 2017. p. 117–57.10.5772/intechopen.70793Search in Google Scholar
[126] Agarwal A, Rana M, Qiu E, AlBunni H, Bui AD, Henkel R. Role of oxidative stress, infection and inflammation in male infertility. Andrologia. 2018;50(11):e13126.10.1111/and.13126Search in Google Scholar PubMed
[127] Lu Z, Sethu R, Imlay JA. Endogenous superoxide is a key effector of the oxygen sensitivity of a model obligate anaerobe. Proc Natl Acad Sci USA. 2018;115(14):E3266–75.10.1073/pnas.1800120115Search in Google Scholar PubMed PubMed Central
[128] Chakraborty SP, Pramanik P, Roy S. Staphylococcus aureus Infection induced oxidative imbalance in neutrophils: Possible protective role of nanoconjugated vancomycin. ISRN Pharmacol. 2012;2012:435214.10.5402/2012/435214Search in Google Scholar PubMed PubMed Central
[129] Meier B, Habermehl GG. Evidence for superoxide dismutase and catalase in mollicutes and release of reactive oxygen species. Free Radic Res Commun. 1991;12-13(Pt 1):451–4.10.3109/10715769109145816Search in Google Scholar PubMed
[130] Fraczek M, Szumala-Kakol A, Jedrzejczak P, Kamieniczna M, Kurpisz M. Bacteria trigger oxygen radical release and sperm lipid peroxidation in in vitro model of semen inflammation. Fertil Steril. 2007;88:1076–85.10.1016/j.fertnstert.2006.12.025Search in Google Scholar PubMed
[131] Huycke MM, Moore D, Joyce W, Wise P, Shepard L, Kotake Y, et al. Extracellular superoxide production by Enterococcus faecalis requires demethylmenaquinone and is attenuated by functional terminal quinol oxidases. Mol Microbiol. 2001;42(3):729–40.10.1046/j.1365-2958.2001.02638.xSearch in Google Scholar PubMed
[132] Wang A, Fanning L, Anderson DJ, Loughlin KR. Generation of reactive oxygen species by leukocytes and sperm following exposure to urogenital tract infection. Arch Androl. 1997;39:11–7.10.3109/01485019708987896Search in Google Scholar PubMed
[133] Ford WC, Whittington K, Williams AC. Reactive oxygen species in human sperm suspensions: production by leukocytes and the generation of NADPH to protect sperm against their effects. Int J Androl. 1997;20(Suppl 3):44–9.Search in Google Scholar
[134] Sanocka D, Jedrzejczak P, Szumała-Kaekol A, Fraczek M, Kurpisz M. Male genital tract inflammation: The role of selected interleukins in regulation of pro-oxidant and antioxidant enzymatic substances in seminal plasma. J Androl. 2003;24(3):448–55.10.1002/j.1939-4640.2003.tb02693.xSearch in Google Scholar PubMed
[135] Flint M, Agarwal A, du Plessis SS. Leukocytospermia and Oxidative Stress. In: Agarwal A, Aitken R, Alvarez J, editors. Studies on men’s health and fertility. Oxidative stress in applied basic research and clinical practice. Totowa: Humana Press; 2012. p. 517–33.10.1007/978-1-61779-776-7_23Search in Google Scholar
[136] Sharma RK, Pasqualotto AE, Nelson DR, Thomas AJ Jr, Agarwal A. Relationship between seminal white blood cell counts and oxidative stress in men treated at an infertility clinic. J Androl. 2001;22(4):575–83.10.1002/j.1939-4640.2001.tb02217.xSearch in Google Scholar
[137] Roca J, Parrilla I, Gil MA, Cuello C, Martinez EA, Rodriguez-Martinez H. Non-viable sperm in the ejaculate: Lethal escorts for contemporary viable sperm. Anim Reprod Sci. 2016;169:24–31.10.1016/j.anireprosci.2016.02.028Search in Google Scholar PubMed
[138] Bustamante-Marín X, Quiroga C, Lavandero S, Reyes JG, Moreno RD. Apoptosis, necrosis and autophagy are influenced by metabolic energy sources in cultured rat spermatocytes. Apoptosis. 2012;17(6):539–50.10.1007/s10495-012-0709-2Search in Google Scholar PubMed
[139] Liu J, Marey MA, Kowsar R, Hambruch N, Shimizu T, Haneda S, et al. An acute-phase protein as a regulator of sperm survival in the bovine oviduct: alpha 1-acid-glycoprotein impairs neutrophil phagocytosis of sperm in vitro. J Reprod Dev. 2014;60(5):342–8.10.1262/jrd.2014-049Search in Google Scholar PubMed PubMed Central
[140] Aitken RJ, Clarkson JS, Fishel S. Generation of reactive oxygen species, lipid peroxidation, and human sperm function. Biol Reprod. 1989;41(1):183–97.10.1095/biolreprod41.1.183Search in Google Scholar PubMed
[141] Ayala A, Muñoz MF, Argüelles S. Lipid peroxidation: production, metabolism, and signaling mechanisms of malondialdehyde and 4-hydroxy-2-nonenal. Oxid Med Cell Longev. 2014;2014:360438.10.1155/2014/360438Search in Google Scholar PubMed PubMed Central
[142] Aitken RJ, Wingate JK, De Iuliis GN, Koppers AJ, McLaughlin EA. Cis-unsaturated fatty acids stimulate reactive oxygen species generation and lipid peroxidation in human spermatozoa. J Clin Endocrinol Metab. 2006;91(10):4154–63.10.1210/jc.2006-1309Search in Google Scholar PubMed
[143] Berlett BS, Stadtman ER. Protein oxidation in aging, disease, and oxidative stress. J Biol Chem. 1997;272:20313–6.10.1074/jbc.272.33.20313Search in Google Scholar PubMed
[144] Mammoto A, Masumoto N, Tahara M, Ikebuchi Y, Ohmichi M, Tasaka K, et al. Reactive oxygen species block sperm-egg fusion via oxidation of sperm sulfhydryl proteins in mice. Biol Reprod. 1996;55:1063–8.10.1095/biolreprod55.5.1063Search in Google Scholar PubMed
[145] Aitken RJ, Baker MA. Causes and consequences of apoptosis in spermatozoa; contributions to infertility and impacts on development. Int J Dev Biol. 2013;57(2–4):265–72.10.1387/ijdb.130146jaSearch in Google Scholar PubMed
[146] Schulz M, Sánchez R, Soto L, Risopatrón J, Villegas J. Effect of Escherichia coli and its soluble factors on mitochondrial membrane potential, phosphatidylserine translocation, viability, and motility of human spermatozoa. Fertil Steril. 2010;94(2):619–23.10.1016/j.fertnstert.2009.01.140Search in Google Scholar PubMed
[147] Moretti E, Collodel G, Mazzi L, Campagna M, Iacoponi F, Figura N. Resistin, interleukin-6, tumor necrosis factor-alpha, and human semen parameters in the presence of leukocytospermia, smoking habit, and varicocele. Fertil Steril. 2014;102(2):354–60.10.1016/j.fertnstert.2014.04.017Search in Google Scholar PubMed
[148] Fraczek M, Hryhorowicz M, Gill K, Zarzycka M, Gaczarzewicz D, Jedrzejczak P, et al. The effect of bacteriospermia and leukocytospermia on conventional and nonconventional semen parameters in healthy young normozoospermic males. J Reprod Immunol. 2016;118:18–27.10.1016/j.jri.2016.08.006Search in Google Scholar PubMed
[149] Fujita Y, Mihara T, Okazaki T, Shitanaka M, Kushino R, Ikeda C, et al. Toll-like receptors (TLR) 2 and 4 on human sperm recognize bacterial endotoxins and mediate apoptosis. Hum Reprod. 2011;26:2799–806.10.1093/humrep/der234Search in Google Scholar PubMed PubMed Central
[150] Satta A, Stivala A, Garozzo A, Morello A, Perdichizzi A, Vicari E, et al. Experimental Chlamydia trachomatis infection causes apoptosis in human sperm. Hum Reprod. 2006;21:134–7.10.1093/humrep/dei269Search in Google Scholar PubMed
[151] Meena GS, Raina VS, Gupta AK, Mohanty TK, Bhakat M, Abdullah M, et al. Effect of preputial washing on bacterial load and preservability of semen in Murrah buffalo bulls. Vet World. 2015;8(6):798–803.10.14202/vetworld.2015.798-803Search in Google Scholar PubMed PubMed Central
[152] Valsa J, Skandhan KP, Gusani PH, Sahab Khan P, Amith S. Quality of 4-hourly ejaculates-levels of calcium and magnesium. Andrologia. 2013;45(1):10–7.10.1111/j.1439-0272.2012.01301.xSearch in Google Scholar PubMed
[153] Yousef MI, Kamel KI, El-Guendi MI, El-Demerdash FM. An in vitro study on reproductive toxicity of aluminium chloride on rabbit sperm: the protective role of some antioxidants. Toxicology. 2007;239(3):213–23.10.1016/j.tox.2007.07.011Search in Google Scholar PubMed
[154] Azab SS, Mostafa T, Abougabal KM, Tohamy AA, Nabil N. Assessment of seminal calcium and magnesium levels in infertile men with varicocele before and after varicocelectomy. Andrology. 2021;9(6):1853–8.10.1111/andr.13066Search in Google Scholar PubMed
[155] Bassey IE, Isong IKP, Sunday Esiere KU, Essien OE, Udoh AE, Akpan UO. Seminal oxidative stress markers, calcium, magnesium, and semen profile of infertile diabetic and nondiabetic Nigerian men. Int J Appl Bas Med Res. 2019;9(3):159–64.10.4103/ijabmr.IJABMR_152_18Search in Google Scholar PubMed PubMed Central
[156] Zakošek Pipan M, Zrimšek P, Jakovac Strajn B, Pavšič Vrtač K, Knific T, Mrkun J. Macro- and microelements in serum and seminal plasma as biomarkers for bull sperm cryotolerance. Acta Vet Scand. 2021;63(1):25.10.1186/s13028-021-00590-2Search in Google Scholar PubMed PubMed Central
[157] Tvrdá E, Kňažická Z, Massanyi P, Lukáč N. Relationships between levels of nitrogen compounds with antioxidant properties and semen quality in bulls. Contemp Agric. 2011;60(3):244–52.Search in Google Scholar
[158] Bartoov B, Ozbonfil D, Maayan MC, Ohad E, Nitzan Y. Virulence characteristics of male genital tract Escherichia coli isolated from semen of suspected infertile men. Andrologia. 1991;23(5):387–94.10.1111/j.1439-0272.1991.tb02586.xSearch in Google Scholar PubMed
[159] Kačániová M, Terentjeva M, Štefániková J, Žiarovská J, Savitskaya T, Grinshpan D, et al. Chemical composition and antimicrobial activity of selected essential oils against Staphylococcus spp. isolated from human semen. Antibiotics. 2020;9(11):1–21.10.3390/antibiotics9110765Search in Google Scholar PubMed PubMed Central
[160] Reiber MA, McInroy JA, Conner DE. Enumeration and identification of bacteria in chicken semen. Poult Sci. 1995;74(5):795–9.10.3382/ps.0740795Search in Google Scholar PubMed
[161] Kumaresan G, Gangwar C, Mishra AK, Kumar A, Kharche SD, Singh NP, et al. Occurrence, molecular characterization and antimicrobial-resistance pattern of Staphylococcus species isolates from buck semen. Arch Microbiol. 2022;204(2):1–10.10.1007/s00203-021-02731-7Search in Google Scholar PubMed
[162] Rivera VV, Maza WDC, Suárez JP. The relationship between sexually transmitted bacteria, microbiota and seminal quality in asymptomatic men. Asian J Urol. 2021, Epub 2021 September 24. 10.1016/j.ajur.2021.09.004.Search in Google Scholar
[163] Galarzo Pardo S, Cano Cháves MA, Puerta Suarez J, Giraldo M, Mayorga B, Cadavid ÁP, et al. Effect of soluble factors from Staphylococcus aureus, Staphylococcus capitis and Staphylococcus epidermidis on sperm functionality. Chilean J Obstet Gyneacol. 2015;80(4):316–23.10.4067/S0717-75262015000400006Search in Google Scholar
[164] Thammavongsa V, Missiakas DM, Schneewind O. Staphylococcus aureus degrades neutrophil extracellular traps to promote immune cell death. Science. 2013;342(6160):863–6.10.1126/science.1242255Search in Google Scholar PubMed PubMed Central
[165] Farahani L, Tharakan T, Yap T, Ramsay JW, Jayasena CN, Minhas S. The semen microbiome and its impact on sperm function and male fertility: a systematic review and meta-analysis. Andrology. 2021;9(1):115–44.10.1111/andr.12886Search in Google Scholar
[166] Moretti E, Capitani S, Figura N, Pammolli A, Federico MG, Giannerini V, et al. The presence of bacteria species in semen and sperm quality. J Assist Reprod Gen. 2009;26(1):47–56.10.1007/s10815-008-9283-5Search in Google Scholar
[167] Mehta RH, Sridhar H, Kumar BV, Kumar TA. High incidence of oligozoospermia and teratozoospermia in human semen infected with the aerobic bacterium Streptococcus faecalis. Reprod Biomed Online. 2002;5(1):17–21.10.1016/S1472-6483(10)61591-XSearch in Google Scholar
[168] Villegas J, Schulz M, Soto L, Sanchez R. Bacteria induce expression of apoptosis in human spermatozoa. Apoptosis. 2005;10(1):105–10.10.1007/s10495-005-6065-8Search in Google Scholar PubMed
[169] Türk S, Korrovits P, Punab M, Mändar R. Coryneform bacteria in semen of chronic prostatitis patients. Int J Androl. 2007;30(2):123–8.10.1111/j.1365-2605.2006.00722.xSearch in Google Scholar PubMed
[170] Meštrović T, Bedenić B, Ljubin-Sternak S, Sviben M, Profozić Z. Ciprofloxacin‐resistant Corynebacterium glucuronolyticum as a cause of male urethritis syndrome. JMM Case Rep. 2014;1(1):1–3.10.1099/jmmcr.0.000208Search in Google Scholar
[171] Novo-Veleiro I, Hernández-Cabrera M, Cañas-Hernández F, Pisos-Álamo E, Francés-Urmeneta A, Delgado-Yagüe M, et al. Paucisymptomatic infectious prostatitis as a cause of fever without an apparent origin. A series of 19 patients. Eur J Clin Microbiol Infect Dis. 2013;32(2):263–8.10.1007/s10096-012-1738-zSearch in Google Scholar PubMed
[172] Curry CR, Saluja K, Das S, Thakral B, Dangle P, Keeler TC, et al. Encrusted cystitis secondary to Corynebacterium glucuronolyticum in a 57-year-old man without predisposing factors. Lab Med. 2015;46(2):136–9.10.1309/LMXQP557EINXBXIFSearch in Google Scholar PubMed
[173] Riegel P, Lepargneur JP. Infection et fertilité—Corynebacterium seminale: point de vue du bactériologiste. Andrologie. 2001;11(3):155–9.10.1007/BF03036640Search in Google Scholar
[174] Dasari S. Recent findings of Lactobacillus diversity and their functional role in vaginal ecosystems. In: Buddolla V, editor. Recent developments in applied microbiology and biochemistry. Cambridge: Academic Press; 2019. p. 3–12.10.1016/B978-0-12-816328-3.00001-5Search in Google Scholar
[175] González-Marín C, Roy R, López-Fernández C, Diez B, Carabaño MJ, Fernández JL, et al. Bacteria in bovine semen can increase sperm DNA fragmentation rates: A kinetic experimental approach. Animal Reprod Sci. 2011;123(3–4):139–48.10.1016/j.anireprosci.2010.11.014Search in Google Scholar PubMed
[176] Weng SL, Chiu CM, Lin FM, Huang WC, Liang C, Yang T, et al. Bacterial communities in semen from men of infertile couples: metagenomic sequencing reveals relationships of seminal microbiota to semen quality. PLoS One. 2014;9(10):1–15.10.1371/journal.pone.0110152Search in Google Scholar PubMed PubMed Central
[177] Barbonetti A, Cinque B, Vassallo MRC, Mineo S, Francavilla S, Cifone MG, et al. Effect of vaginal probiotic lactobacilli on in vitro–induced sperm lipid peroxidation and its impact on sperm motility and viability. Fertil Steril. 2011;95(8):2485–8.10.1016/j.fertnstert.2011.03.066Search in Google Scholar PubMed
[178] Gallegos G, Ramos B, Santiso R, Goyanes V, Gosálvez J, Fernández JL. Sperm DNA fragmentation in infertile men with genitourinary infection by Chlamydia trachomatis and Mycoplasma. Fertil Steril. 2008;90(2):328–34.10.1016/j.fertnstert.2007.06.035Search in Google Scholar PubMed
[179] Gdoura R, Kchaou W, Chaari C, Znazen A, Keskes L, Rebai T, et al. Ureaplasma urealyticum, Ureaplasma parvum, Mycoplasma hominis and Mycoplasma genitalium infections and semen quality of infertile men. BMC Infect Dis. 2007;7:1–9.10.1186/1471-2334-7-129Search in Google Scholar PubMed PubMed Central
[180] Jakiel G, Robak-Chołubek D, Wieczorek P, Bokiniec M. Evaluation of some parameters of human semen with positive chlamydial reaction. Ann Univ Mariae Curie Sklodowska Med. 2004;59(2):61–4.Search in Google Scholar
[181] Bezold G, Politch JA, Kiviat NB, Kuypers JM, Wolff H, Anderson DJ. Prevalence of sexually transmissible pathogens in semen from asymptomatic male infertility patients with and without leukocytospermia. Fertil Steril. 2007;87(5):1087–97.10.1016/j.fertnstert.2006.08.109Search in Google Scholar PubMed PubMed Central
[182] Al-Mously N, Eley A. Transient exposure to Chlamydia trachomatis can induce alteration of sperm function which cannot be stopped by sperm washing. Middle East Fertil Soc J. 2015;20(1):48–53.10.1016/j.mefs.2014.04.003Search in Google Scholar
[183] Eckert T, Goericke-Pesch S, Heydel C, Bergmann M, Kauffold J, Failing K, et al. Interaction of different Chlamydiae species with bovine spermatozoa. BMC Microbiol. 2019;19(1):1–9.10.1186/s12866-019-1392-zSearch in Google Scholar PubMed PubMed Central
[184] Tjagur S, Mändar R, Poolamets O, Pomm K, Punab M. Mycoplasma genitalium provokes seminal inflammation among infertile males. Int J Mol Sci. 2021;22(24):1–16.10.3390/ijms222413467Search in Google Scholar PubMed PubMed Central
[185] Veznik Z, Pospisil L, Svecova D, Zajicova A, Unzeitig V. Chlamydiae in the ejaculate: their influence on the quality and morphology of sperm. Acta Obstet Gynecol Scand. 2004;83(7):656–60.10.1111/j.0001-6349.2004.00542.xSearch in Google Scholar PubMed
[186] Svenstrup HF, Fedder J, Abraham-Peskir J, Birkelund S, Christiansen G. Mycoplasma genitalium attaches to human spermatozoa. Hum Reprod. 2003;18(10):2103–9.10.1093/humrep/deg392Search in Google Scholar
[187] Fowlkes DM, MacLeod J, O’Leary WM. T-mycoplasmas and human infertility: correlation of infection with alterations in seminal parameters. Fertil Steril. 1975;26(12):1212–8.10.1016/S0015-0282(16)41537-2Search in Google Scholar
[188] Sanocka-Maciejewska D, Ciupińska M, Kurpisz M. Bacterial infection and semen quality. J Reprod Immunol. 2005;67(1–2):51–6.10.1016/j.jri.2005.06.003Search in Google Scholar PubMed
[189] Lee JS, Kim KT, Lee HS, Yang KM, Seo JT, Choe JH. Concordance of Ureaplasma urealyticum and Mycoplasma hominis in infertile couples: impact on semen parameters. Urology. 2013;81(6):1219–24.10.1016/j.urology.2013.02.044Search in Google Scholar PubMed
[190] Diemer T, Weidner W, Michelmann HW, Schiefer HG, Rovan E, Mayer F. Influence of Escherichia coli on motility parameters of human spermatozoa in vitro. Int J Androl. 1996;19(5):271–7.10.1111/j.1365-2605.1996.tb00475.xSearch in Google Scholar PubMed
[191] Diemer T, Huwe P, Ludwig M, Hauck EW, Weidner W. Urogenital infection and sperm motility. Andrologia. 2003;35(5):283–7.10.1111/j.1439-0272.2003.tb00858.xSearch in Google Scholar
[192] Barbonetti A, Vassallo MR, Cinque B, Filipponi S, Mastromarino P, Cifone MG, et al. Soluble products of Escherichia coli induce mitochondrial dysfunction-related sperm membrane lipid peroxidation which is prevented by lactobacilli. PLoS One. 2013;8(12):1–10.10.1371/journal.pone.0083136Search in Google Scholar PubMed PubMed Central
[193] Rana K, Prabha V. Sperm agglutinating Escherichia coli and male infertility: An in vivo study. Ann Infertil Reprod Endocrinol. 2018;1(2):1–7.Search in Google Scholar
[194] Isaiah IN, Nche BT, Nwagu IG, Nnanna II. Current studies on bacterospermia the leading cause of male infertility: a protégé and potential threat towards mans extinction. N Am J Med Sci. 2011;3(12):562–4.10.4297/najms.2011.3559Search in Google Scholar PubMed PubMed Central
[195] Kaur S, Prabha V. Infertility as a consequence of spermagglutinating Staphylococcus aureus colonization in genital tract of female mice. PLoS One. 2012;7(12):1–8.10.1371/journal.pone.0052325Search in Google Scholar PubMed PubMed Central
[196] Esmailkhani A, Akhi MT, Sadeghi J, Niknafs B, Zahedi Bialvaei A, Farzadi L, et al. Assessing the prevalence of Staphylococcus aureus in infertile male patients in Tabriz, northwest Iran. Int J Reprod Biomed. 2018;16(7):469–74.10.29252/ijrm.16.7.469Search in Google Scholar
[197] Gupta S, Prabha V. Human sperm interaction with Staphylococcus aureus: a molecular approach. J Pathog. 2012;2012:1–7.10.1155/2012/816536Search in Google Scholar
[198] Onemu SO, Ibeh IN. Studies on the significance of positive bacterial semen cultures in male fertility in Nigeria. Int J Fertil Womens Med. 2001;46(4):210–4.Search in Google Scholar
[199] Berktas M, Aydin S, Yilmaz Y, Cecen K, Bozkurt H. Sperm motility changes after coincubation with various uropathogenic microorganisms: an in vitro experimental study. Int Urol Nephrol. 2008;40(2):383–9.10.1007/s11255-007-9289-4Search in Google Scholar
[200] Zeyad A, Hamad MF, Hammadeh ME. The effects of bacterial infection on human sperm nuclear protamine P1/P2 ratio and DNA integrity. Andrologia. 2018;50(2):1–9.10.1111/and.12841Search in Google Scholar
[201] Vilvanathan S, Kandasamy B, Jayachandran AL, Sathiyanarayanan S, Tanjore Singaravelu V, Krishnamurthy V, et al. Bacteriospermia and its impact on basic semen parameters among infertile men. Interdiscip Perspect Infect Dis. 2016;2016:1–6.10.1155/2016/2614692Search in Google Scholar
[202] Aggarwal J, Prabha V. Contraceptive effect of sperm-agglutinating factor isolated from Staphylococcus aureus in mouse. BJOG. 2006;113(9):1039–43.10.1111/j.1471-0528.2006.01024.xSearch in Google Scholar
[203] Li J, Li B, Song J, Liu H, Bi W, Dong G, et al. Characteristic and mechanism of immobilization effect of Staphylococcus aureus on human spermatozoa. Microb Pathog. 2018;119:28–34.10.1016/j.micpath.2018.03.049Search in Google Scholar
[204] Upadhyaya M, Hibbard BM, Walker SM. The effect of Ureaplasma urealyticum on semen characteristics. Fertil Steril. 1984;41(2):304–8.10.1016/S0015-0282(16)47609-0Search in Google Scholar
[205] Talazac N, Mansat A, Chabanon G, Pontonnier F, Plante P, Perie N, de Jong Z. Comparison of the incidence of Ureaplasma urealyticum in infertile men and in donors of semen. Eur Urol. 1990;18:127–31.10.1159/000463889Search in Google Scholar PubMed
[206] Núñez-Calonge R, Caballero P, Redondo C, Baquero F, Martínez-Ferrer M, Meseguer MA. Ureaplasma urealyticum reduces motility and induces membrane alterations in human spermatozoa. Hum Reprod. 1998;13(10):2756–61.10.1093/humrep/13.10.2756Search in Google Scholar PubMed
[207] Zhang J, Liu H, Yang Q, Li P, Wen Y, Han X, et al. Genomic Sequencing Reveals the Diversity of Seminal Bacteria and Relationships to Reproductive Potential in Boar Sperm. Front Microbiol. 2020;11:1–16.10.3389/fmicb.2020.01873Search in Google Scholar PubMed PubMed Central
[208] Ricci S, De Giorgi S, Lazzeri E, Luddi A, Rossi S, Piomboni P, et al. Impact of asymptomatic genital tract infections on in vitro Fertilization (IVF) outcome. PLoS One. 2018;13(11):1–16.10.1371/journal.pone.0207684Search in Google Scholar PubMed PubMed Central
[209] Cardoso EM, Santoianni JE, De Paulis AN, Andrada JA, Predari SC, Arregger AL. Improvement of semen quality in infected asymptomatic infertile male after bacteriological cure. Medicina (B Aires). 1998;58(2):160–4.Search in Google Scholar
[210] Sepúlveda L, Bussalleu E, Yeste M, Bonet S. Effect of Pseudomonas aeruginosa on sperm capacitation and protein phosphorylation of boar spermatozoa. Theriogenology. 2016;85(8):1421–31.10.1016/j.theriogenology.2015.12.025Search in Google Scholar PubMed
[211] Sepúlveda L, Bussalleu E, Yeste M, Bonet S. Effects of different concentrations of Pseudomonas aeruginosa on boar sperm quality. Anim Reprod Sci. 2014;150(3–4):96–106.10.1016/j.anireprosci.2014.09.001Search in Google Scholar PubMed
[212] Negi S, Vander H, Chauhan A, Rana K, Prabha V. Microbial sperm immobilization factor from Pseudomonas aeruginosa as a contraceptive agent: an experimental study. Ann Infertil Reprod Endocrinol. 2018;1(1):1–6.Search in Google Scholar
[213] Diemer T, Huwe P, Michelmann HW, Mayer F, Schiefer HG, Weidner W. Escherichia coli-induced alterations of human spermatozoa. An electron microscopy analysis. Int J Androl. 2000;23(3):178–86.10.1046/j.1365-2605.2000.00224.xSearch in Google Scholar PubMed
[214] Lang T, Dechant M, Sanchez V, Wistuba J, Boiani M, Pilatz A, et al. Structural and functional integrity of spermatozoa is compromised as a consequence of acute uropathogenic E. coli-associated epididymitis. Biol Reprod. 2013;89(3):1–10.10.1095/biolreprod.113.110379Search in Google Scholar
[215] Answal M, Prabha V. Escherichia coli recombinant sperm immobilizing factor RecX as a potential vaginal contraceptive. Reprod Biol Endocrinol. 2018;16(1):1–9.10.1186/s12958-018-0407-1Search in Google Scholar PubMed PubMed Central
[216] Sukarjati S, Amilah S, Sudjarwo S. Toxicity of 32.2 kDa MW Escherichia coli pili adhesin isolated from infertile male semen in reproductive system. Folia Med Indones. 2018;54(2):146–54.10.20473/fmi.v54i2.8866Search in Google Scholar
[217] Galdiero F, Gorga F, Bentivoglio C, Mancuso R, Galdiero E, Tufano MA. The action of LPS porins and peptidoglycan fragments on human spermatozoa. Infection. 1988;16(6):349–53.10.1007/BF01644545Search in Google Scholar PubMed
[218] Sharma T, Chauhan A, Thaper D, Rana K, Gupta S, Prabha V. Antifertility effects of sperm impairing factors isolated from bacteria in male mice. J Microbiol Exp. 2017;5(2):1–5.10.15406/jmen.2017.05.00141Search in Google Scholar
[219] Xia XY, An LM, Li WW, Li K, Shao Y, Shang XJ, et al. Ureaplasma urealyticum infection affects sperm plasma membrane integrity in infertile men. Zhonghua Nan Ke Xue. 2011;17(12):1069–72.Search in Google Scholar
[220] Díaz-García FJ, Flores-Medina S. Relación entre infertilidad masculina e infección genitourinaria por micoplasmas: Una actualización. Perinatol Reprod Hum. 2013;27(1):21–34.Search in Google Scholar
[221] Segnini A, Camejo MI, Proverbio F. Chlamydia trachomatis and sperm lipid peroxidation in infertile men. Asian J Androl. 2003;5(1):47–9.Search in Google Scholar
[222] Pérez-Soto E, Fernández-Martínez E, Oros-Pantoja R, Medel-Flores O, Miranda-Covarrubias JC, Sánchez-Monroy V. Proinflammatory and oxidative stress states induced by human Papillomavirus and Chlamydia trachomatis coinfection affect sperm quality in asymptomatic infertile men. Medicina (Kaunas). 2021;57(9):1–9.10.3390/medicina57090862Search in Google Scholar PubMed PubMed Central
[223] Bin DH, Wang SY, Zhou Q, He QH. Zhibai Dihuang Decoction improves sperm mitochondrial permeability transition in rats with ureaplasma urealyticum infection. Zhonghua Nan Ke Xue. 2018;24(6):540–6.Search in Google Scholar
[224] Guo JH, Li YQ, Guo XZ, Liu CS, He QH. Effects of Zhibai Dihuang Decoction on mitochondrial cytochrome oxidase in the spermatogenic cells of rats with ureaplasma urealyticum infection. Zhonghua Nan Ke Xue. 2017;23(8):722–7.Search in Google Scholar
[225] Huwe P, Diemer T, Ludwig M, Liu J, Schiefer HG, Weidner W. Influence of different uropathogenic microorganisms on human sperm motility parameters in an in vitro experiment. Andrologia. 1998;30(Suppl 1):55–9.10.1111/j.1439-0272.1998.tb02827.xSearch in Google Scholar PubMed
[226] El-Mulla KF, Köhn FM, Dandal M, El Beheiry AH, Schiefer HG, Weidner W, et al. In vitro effect of Escherichia coli on human sperm acrosome reaction. Arch Androl. 1996;37(2):73–8.10.3109/01485019608988505Search in Google Scholar PubMed
[227] Rodin DM, Larone D, Goldstein M. Relationship between semen cultures, leukospermia, and semen analysis in men undergoing fertility evaluation. Fertil Steril. 2003;79(Suppl 3):1555–8.10.1016/S0015-0282(03)00340-6Search in Google Scholar
[228] Xu C, Sun GF, Zhu YF, Wang YF. The correlation of Ureaplasma urealyticum infection with infertility. Andrologia. 1997;29(4):219–26.10.1111/j.1439-0272.1997.tb00319.xSearch in Google Scholar PubMed
[229] De Francesco MA, Negrini R, Ravizzola G, Galli P, Manca N. Bacterial species present in the lower male genital tract: a five-year retrospective study. Eur J Contracept Reprod Health Care. 2011;16(1):47–53.10.3109/13625187.2010.533219Search in Google Scholar PubMed
[230] Rodríguez AG, Corés CG, Forero LYP. Estudio retrospectivo en el diagnóstico de Mycoplasma y Ureaplasma en muestra seminal de 89 pacientes en la Ciudad de México. Rev Fac Med UNAM. 2015;58(1):5–12.Search in Google Scholar
[231] Zhang ZH, Zhang HG, Dong Y, Han RR, Dai RL, Liu RZ. Ureaplasma urealyticum in male infertility in Jilin Province, North-east China, and its relationship with sperm morphology. J Int Med Res. 2011;39(1):33–40.10.1177/147323001103900104Search in Google Scholar PubMed
[232] Mazzoli S, Cai T, Rupealta V, Gavazzi A, Castricchi Pagliai R, Mondaini N, et al. Interleukin 8 and anti-chlamydia trachomatis mucosal IgA as urogenital immunologic markers in patients with C. trachomatis prostatic infection. Eur Urol. 2007;51(5):1385–93.10.1016/j.eururo.2006.10.059Search in Google Scholar PubMed
[233] Feng Q, Ma ZW, Wang Y, Qiu MX. Correlation of Mycoplasma genitalium infection with semen parameters and sperm DNA integrity in male infertility patients. Zhonghua Nan Ke Xue. 2020;26(10):900–5.Search in Google Scholar
[234] Moazenchi M, Totonchi M, Salman Yazdi R, Hratian K, Mohseni Meybodi MA, Ahmadi Panah, et al. The impact of Chlamydia trachomatis infection on sperm parameters and male fertility: A comprehensive study. Int J STD AIDS. 2018;29(5):466–73.10.1177/0956462417735245Search in Google Scholar PubMed
[235] Dehghan Marvast L, Talebi AR, Ghasemzadeh J, Hosseini A, Pacey AA. Effects of Chlamydia trachomatis infection on sperm chromatin condensation and DNA integrity. Andrologia. 2018;50(3):1–7.10.1111/and.12918Search in Google Scholar PubMed
[236] Liu KS, Mao XD, Pan F, An RF. Effect and mechanisms of reproductive tract infection on oxidative stress parameters, sperm DNA fragmentation, and semen quality in infertile males. Reprod Biol Endocrinol. 2021;19(1):1–12.10.1186/s12958-021-00781-6Search in Google Scholar PubMed PubMed Central
[237] Ma XP, Gao XQ. The effect of Ureaplasma urealyticum on the level of P34H expression, the activity of hyaluronidase, and DNA fragmentation in human spermatozoa. Am J Reprod Immunol. 2017;77(1):1–9.10.1111/aji.12600Search in Google Scholar PubMed
[238] Reichart M, Kahane I, Bartoov B. In vivo and in vitro impairment of human and ram sperm nuclear chromatin integrity by sexually transmitted Ureaplasma urealyticum infection. Biol Reprod. 2000;63(4):1041–8.10.1095/biolreprod63.4.1041Search in Google Scholar PubMed
[239] Jangra I, Chauhan A, Prabha V. Synergistic interactions of sperm impairing bacteria: Impact on pregnancy outcome in mouse model. Clin J Obstet Gynecol. 2021;4:33–9.10.29328/journal.cjog.1001083Search in Google Scholar
[240] Kaur K, Kaur S, Prabha V. Exploitation of sperm-Escherichia coli interaction at the receptor-ligand level for the development of anti-receptor antibodies as the vaginal contraceptive. Andrology. 2015;3(2):385–94.10.1111/andr.290Search in Google Scholar
[241] Comhaire FH, Dekretser D, Farley TMM, Rowe PJ. Towards more objectivity in diagnosis and management of male-fertility. Int J Androl. 1987;7:R3–53.Search in Google Scholar
[242] Politch JA, Mayer KH, Abbott AF, Anderson DJ. The effects of disease progression and zidovudine therapy on semen quality in human immunodeficiency virus type 1 seropositive men. Fertil Steril. 1994;61(5):922–8.10.1016/S0015-0282(16)56707-7Search in Google Scholar
[243] Rowe PJ, Comhaire FH, Hargreave TB, Mahmoud AM. WHO manual for standardized investigation and diagnosis of the infertile male. 1st edn. Cambridge: Cambridge University Press; 2000.Search in Google Scholar
[244] Schuppe HC, Pilaty A, Hossain H, Diemer T, Qagenlehner F, Weidner W. Urogenital infection as a risk factor for male infertility. Dtsch Arztebl Int. 2017;114(19):339–46.10.3238/arztebl.2017.0339Search in Google Scholar
[245] Scheifer HG. Microbiology of male urethroadnexitis: diagnostic procedures and criteria for aetiologic classification. Andrologia. 1998;30(1):7–13.10.1111/j.1439-0272.1998.tb02820.xSearch in Google Scholar
[246] Cottell E, Harrison RF, McCaffrey M, Walsh T, Mallon E, Barry-Kinsella C. Are seminal fluid microorganisms of significance or merely contaminants? Fertil Steril. 2000;74(3):465–70.10.1016/S0015-0282(00)00709-3Search in Google Scholar
[247] Weidner W, Pilatz A, Diemer T, Schuppe HC, Rusz A, Wagenlehner F. Male urogenital infections: impact of infection and inflammation on ejaculate parameters. World J Urol. 2013;31(4):717–23.10.1007/s00345-013-1082-7Search in Google Scholar PubMed
[248] Mazzoli S, Cai T, Addonisio P, Bechi A, Mondaini N, Bartoletti R. Chlamydia trachomatis infection is related to poor semen quality in young prostatitis patients. Eur Urol. 2010;57(4):708–14.10.1016/j.eururo.2009.05.015Search in Google Scholar PubMed
[249] Rybar R, Prinosilova P, Kopecka V, Hlavicova J, Veznik Z, Zajicova A, et al. The effect of bacterial contamination of semen on sperm chromatin integrity and standard semen parameters in men from infertile couples. Andrologia. 2012;44:410–8.10.1111/j.1439-0272.2011.01198.xSearch in Google Scholar PubMed
[250] Qing L, Song QX, Feng JL, Li HZ, Liu G, Jiang HH. Prevalence of Chlamydia trachomatis, Neisseria gonorrhoeae, Mycoplasma genitalium and Ureaplasma urealyticum infections using a novel isothermal simultaneous RNA amplification testing method in infertile males. Annals Clin Microbiol Antimicrob. 2007;16(1):1–7.10.1186/s12941-017-0220-2Search in Google Scholar PubMed PubMed Central
[251] Eini F, Kutenaei MA, Zareei F, Dastjerdi ZS, Shirzeyli MH, Salehi E. Effect of bacterial infection on sperm quality and DNA fragmentation in subfertile men with Leukocytospermia. BMC Mol Cell Biol. 2021;22(1):1–10.10.1186/s12860-021-00380-8Search in Google Scholar
[252] Ibadin OK, Ibeh IN. Bacteriospermia and sperm quality in infertile male patient at University of Benin Teaching Hospital, Benin City, Nigeria. Malays. J Microbiol. 2008;4(2):65–7.10.21161/mjm.12108Search in Google Scholar
[253] Golshani M, Taheri S, Eslami G, Suleimani Rhabar AA, Fallah F, Goudarzi H. Genital tract infection in asymptomatic infertile men and its effect on semen quality. Iran J Public Health. 2006;35(3):81–4.Search in Google Scholar
[254] Pajovic B, Radojevic N, Vukovic M, Stjepcevic A. Semen analysis before and after antibiotic treatment of asymptomatic Chlamydia‐and Ureaplasma‐related pyospermia. Andrologia. 2013;45(4):266–71.10.1111/and.12004Search in Google Scholar
[255] Bunn TW, Sikarwar AS. Diagnostics: conventional versus modern methods. J Adv Med Pharm Sci. 2016;8(4):1–7.10.9734/JAMPS/2016/25959Search in Google Scholar
[256] Żukowska ME. Advanced methods of bacteriological identification in a clinical microbiology laboratory. J Pre-Clin Clin Res. 2021;15(2):68–72.10.26444/jpccr/134646Search in Google Scholar
[257] Skau PA, Folstad I. Do bacterial infections cause reduced ejaculate quality? A meta-analysis of antibiotic treatment of male infertility. Behav Ecol. 2003;14(1):40–7.10.1093/beheco/14.1.40Search in Google Scholar
[258] Idelevich EA, Reischl U, Becker K. New microbiological techniques in the diagnosis of bloodstream infections. Dtsch Arztebl Int. 2018;115(49):822–32.10.3238/arztebl.2018.0822Search in Google Scholar
[259] Yang S, Rothman RE. PCR-based diagnostics for infectious diseases: uses, limitations, and future applications in acute-care settings. Lancet Infect Dis. 2004;4(6):337–48.10.1016/S1473-3099(04)01044-8Search in Google Scholar
[260] Buchan BW, Ledeboer NA. Emerging technologies for the clinical microbiology laboratory. Clin Microbiol Rev. 2014;27(4):783–822.10.1128/CMR.00003-14Search in Google Scholar PubMed PubMed Central
[261] Shu Y, Prokai D, Berga S, Taylor R, Johnston-MacAnanny E. Transfer of IVF-contaminated blastocysts with removal of the zona pellucida resulted in live births. J Assist Reprod Genet. 2016;33(10):1385–8.10.1007/s10815-016-0776-3Search in Google Scholar PubMed PubMed Central
[262] Štšepetova J, Baranova J, Simm J, Parm Ü, Rööp T, Sokmann S, et al. The complex microbiome from native semen to embryo culture environment in human in vitro fertilization procedure. Reprod Biol Endocrinol. 2020;18(1):1–13.10.1186/s12958-019-0562-zSearch in Google Scholar PubMed PubMed Central
[263] Witkin SS. Immunological aspects of genital chlamydia infections. Best Prac Res Clin Obstet Gynaecol. 2002;16(6):865–74.10.1053/beog.2002.0326Search in Google Scholar PubMed
[264] Boers SA, Jansen R, Hays JP. Understanding and overcoming the pitfalls and biases of next-generation sequencing (NGS) methods for use in the routine clinical microbiological diagnostic laboratory. Eur J Clin Microbiol Infect Dis. 2019;38(6):1059–70.10.1007/s10096-019-03520-3Search in Google Scholar PubMed PubMed Central
[265] Kačániová M, Kunová S, Nagyová Ľ, Horská E, Haščík P. Identifikácia mikroorganizmov vyizolovaných z mliečnych výrobkov za pomoci hmotnostnej spektrometrie MALDI-TOF MS Biotyper a ich antibiotická rezistencia. 1st edn. Ostrava: Key Publishing; 2018.Search in Google Scholar
[266] Croxatto A, Prod’hom G, Greub G. Applications of MALDI-TOF mass spectrometry in clinical diagnostic microbiology. FEMS Microbiol Rev. 2012;36(2):380–407.10.1111/j.1574-6976.2011.00298.xSearch in Google Scholar PubMed
[267] Singhal N, Kumar M, Kanaujia PK, Virdi JS. MALDI-TOF mass spectrometry: an emerging technology for microbial identification and diagnosis. Front Microbiol. 2015;6:1–16.10.3389/fmicb.2015.00791Search in Google Scholar PubMed PubMed Central
[268] Zampieri D, Santos VG, Braga PA, Ferreira CR, Ballottin D, Tasic L, et al. Microorganisms in cryopreserved semen and culture media used in the in vitro production (IVP) of bovine embryos identified by matrix-assisted laser desorption ionization mass spectrometry (MALDI-MS). Theriogenology. 2013;80(4):337–45.10.1016/j.theriogenology.2013.04.020Search in Google Scholar PubMed
[269] Li W, Sun E, Wang Y, Pan H, Zhang Y, Li Y, et al. Rapid identification and antimicrobial susceptibility testing for urinary tract pathogens by direct analysis of urine samples using a MALDI-TOF MS-based combined protocol. Front Microbiol. 2019;10:1–10.10.3389/fmicb.2019.01182Search in Google Scholar PubMed PubMed Central
[270] Florio W, Baldeschi L, Rizzato C, Tavanti A, Ghelardi E, Lupetti A. Detection of antibiotic-resistance by MALDI-TOF mass spectrometry: an expanding area. Front Cell Infect Microbiol. 2020;10:1–7.10.3389/fcimb.2020.572909Search in Google Scholar PubMed PubMed Central
[271] Tvrdá E, Belić L, Ďuračka M, Kováčik A, Kačániová M, Lukáč N. The presence of bacterial species in bovine semen and their impact on the sperm quality. Anim Reprod Sci. 2018;194:e3.10.1016/j.anireprosci.2018.04.012Search in Google Scholar
[272] Ďuračka M, Tvrda E. The presence of bacterial species in boar semen and their impact on the sperm quality and oxidative balance. J Anim Sci. 2018;96:501.10.1093/jas/sky404.1094Search in Google Scholar
[273] Barberis C, Almuzara M, Join-Lambert O, Ramírez MS, Famiglietti A, Vay C. Comparison of the Bruker MALDI-TOF mass spectrometry system and conventional phenotypic methods for identification of Gram-positive rods. PLoS One. 2014;9(9):1–6.10.1371/journal.pone.0106303Search in Google Scholar PubMed PubMed Central
[274] Schröttner P, Gunzer F, Schüppel J, Rudolph WW. Identification of Rare Bacterial Pathogens by 16S rRNA Gene Sequencing and MALDI-TOF MS. J Vis Exp. 2016;113:1–13.10.3791/53176Search in Google Scholar PubMed PubMed Central
[275] Mellmann A, Cloud J, Maier T, Keckevoet U, Ramminger I, Iwen P, et al. Evaluation of matrix-assisted laser desorption ionization-time-of-flight mass spectrometry in comparison to 16S rRNA gene sequencing for species identification of nonfermenting bacteria. J Clin Microbiol. 2008;46(6):1946–54.10.1128/JCM.00157-08Search in Google Scholar PubMed PubMed Central
[276] Morrell JM, Mayer I. Reproduction biotechnologies in germplasm banking of livestock species: a review. Zygote. 2017;25(5):545–7.10.1017/S0967199417000442Search in Google Scholar PubMed
[277] Foote RH. The history of artificial insemination: Selected notes and notables. J Anim Sci. 2010;80:1–10.10.2527/animalsci2002.80E-Suppl_21aSearch in Google Scholar
[278] Morrell JM, Wallgren M. Removal of bacteria from boar ejaculates by Single Layer Centrifugation can reduce the use of antibiotics in semen extenders. Anim Reprod Sci. 2011;123(1–2):64–9.10.1016/j.anireprosci.2010.11.005Search in Google Scholar PubMed
[279] Spinosa HS, Gorniak SL, Bernardi MM. Farmacologia aplicada à medicina veterinária. 5th edn. Rio de Janeiro: Guanabara Koogan; 2011.Search in Google Scholar
[280] Andrabi SMH, Ahmad N, Abbas A, Anzar M. Effect of two different antibiotic combinations on fertility of frozen buffalo and Sahiwal bull semen. Pak Vet J. 2001;21(4):166–9.Search in Google Scholar
[281] Akhter S, Ansari MS, Andrabi S, Ullah N, Qayyum M. Effect of antibiotics in extender on bacterial and spermatozoal quality of cooled buffalo (Bubalus bubalis) bull semen. Reprod Domest Anim. 2008;43(3):272–8.10.1111/j.1439-0531.2007.00890.xSearch in Google Scholar PubMed
[282] Andrabi SM, Khan LA, Shahab M. Isolation of bacteria in semen and evaluation of antibiotics in extender for cryopreservation of buffalo (Bubalus bubalis) bull spermatozoa. Andrologia. 2016;48(10):1166–74.10.1111/and.12555Search in Google Scholar PubMed
[283] Costinar L, Herman V, Pitoiu E, Iancu I, Degi J, Hulea A, et al. Boar semen contamination: Identification of Gram-negative bacteria and antimicrobial resistance profile. Animals (Basel). 2021;12(1):1–10.10.3390/ani12010043Search in Google Scholar PubMed PubMed Central
[284] Faisal AJ, Salman HA. Determination of semen quality and antibacterial susceptibility pattern of bacteria isolated from semen of Iraqi subjects. Microbiol Biotechnol Lett. 2021;49(4):587–93.10.48022/mbl.2108.08006Search in Google Scholar
[285] Maroto Martín LO, Muñoz EC, De Cupere F, Van Driessche E, Echemendia-Blanco D, Rodríguez JM, et al. Bacterial contamination of boar semen affects the litter size. Anim Reprod Sci. 2010;120(1–4):95–104.10.1016/j.anireprosci.2010.03.008Search in Google Scholar PubMed
[286] Bresciani C, Cabassi CS, Morini G, Taddei S, Bettini R, Bigliardi E, et al. Boar semen bacterial contamination in Italy and antibiotic efficacy in a modified extender. Ital J Anim Sci. 2014;13(1):83–7.10.4081/ijas.2014.3082Search in Google Scholar
[287] Alford JA. The occurrence of bacteria resistant to penicillin, streptomycin, and sulfanilamide in diluted bull semen. J Dairy Sci. 1953;36(10):1097.10.3168/jds.S0022-0302(53)91603-8Search in Google Scholar
[288] Goularte KL, Voloski FLS, Redú JFM, Ferreira CER, Vieira AD, Duval EH, et al. Antibiotic resistance in microorganisms isolated in a bull semen stud. Reprod Domest Anim. 2020;55(3):318–24.10.1111/rda.13621Search in Google Scholar PubMed
[289] Dalmutt AC, Moreno LZ, Gomes VTM, Cunha MPV, Barbosa MRF, Sato MIZ, et al. Characterization of bacterial contaminants of boar semen: Identification by MALDI-TOF mass spectrometry and antimicrobial susceptibility profiling. J App Anim Res. 2020;48(1):559–65.10.1080/09712119.2020.1848845Search in Google Scholar
[290] Morrell J. Colloids: Applications in sperm preparation for assisted reproduction. 1st edn. London: IntechOpen; 2016.10.5772/64898Search in Google Scholar
[291] Blomqvist G, Persson M, Wallgren M, Wallgren P, Morrell JM. Removal of virus from boar semen spiked with porcine circovirus type 2. Anim Reprod Sci. 2011;126(1–2):108–14.10.1016/j.anireprosci.2011.04.014Search in Google Scholar PubMed
[292] Fourie J, Loskutoff N, Huyser C. Elimination of bacteria from human semen during sperm preparation using density gradient centrifugation with a novel tube insert. Andrologia. 2012;44:513–7.10.1111/j.1439-0272.2011.01217.xSearch in Google Scholar PubMed
[293] Morrell JM, Klein C, Lundeheim N, Erol E, Troedsson MH. Removal of bacteria from stallion semen by colloid centrifugation. Anim Reprod Sci. 2014;145(1–2):47–53.10.1016/j.anireprosci.2014.01.005Search in Google Scholar PubMed
[294] Du Y. Single-layer density gradient centrifugation is a simple and effective sperm preparation approach in decreasing the incidence of the contamination originated in the potential pathogens in human sperm samples during IVF practice. Fertil Steril. 2020;114(3):e137.10.1016/j.fertnstert.2020.08.406Search in Google Scholar
[295] Morrell JM, Núñez-González A, Crespo-Félez I, Martínez-Martínez S, Martínez Alborcia MJ, Fernández-Alegre E, et al. Removal of bacteria from boar semen using a low-density colloid. Theriogenology. 2019;126:272–8.10.1016/j.theriogenology.2018.12.028Search in Google Scholar PubMed
[296] Tvrdá E, Michalko J, Árvay J, Vukovic NL, Ivanišová E, Ďuračka M, et al. Characterization of the Omija (Schisandra chinensis) extract and its effects on the bovine sperm vitality and oxidative profile during in vitro storage. Evid Based Complement Alternat Med. 2020;2020:1–15.10.1155/2020/7123780Search in Google Scholar PubMed PubMed Central
[297] Elmi A, Prosperi A, Zannoni A, Bertocchi M, Scorpio DG, Forni M, et al. Antimicrobial capabilities of non-spermicidal concentrations of tea tree (Melaleuca alternifolia) and rosemary (Rosmarinus officinalis) essential oils on the liquid phase of refrigerated swine seminal doses. Res Vet Sci. 2019;127:76–81.10.1016/j.rvsc.2019.10.014Search in Google Scholar PubMed
[298] Ros-Santaella JL, Pintus E. Plant extracts as alternative additives for sperm preservation. Antioxidants (Basel). 2021;10:1–25.10.3390/antiox10050772Search in Google Scholar PubMed PubMed Central
[299] Nimrat S, Noppakun S, Sripuak K, Boonthai T, Vuthiphandchai V. Cryopreservation of banana shrimp (Fenneropenaeus merguiensis) spermatophores with supplementation of medicinal plant extracts: Development of a programmable controlled-rate method and a practical method. Aquaculture. 2020;515:1–11.10.1016/j.aquaculture.2019.734537Search in Google Scholar
[300] Bouayed J, Bohn T. Exogenous antioxidants-Double-edged swords in cellular redox state: Health beneficial effects at physiologic doses versus deleterious effects at high doses. Oxid Med Cell Longev. 2010;3(4):228–37.10.4161/oxim.3.4.12858Search in Google Scholar PubMed PubMed Central
[301] Tsakmakidis IA, Samaras T, Anastasiadou S, Basioura A, Ntemka A, Michos I, et al. Iron oxide nanoparticles as an alternative to antibiotics additive on extended boar semen. Nanomaterials (Basel). 2020;10(8):1–16.10.3390/nano10081568Search in Google Scholar PubMed PubMed Central
[302] Yousef MS, Abdelhamid HN, Hidalgo M, Fathy R, Gómez-Gascón L, Dorado J. Antimicrobial activity of silver-carbon nanoparticles on the bacterial flora of bull semen. Theriogenology. 2021;161:219–27.10.1016/j.theriogenology.2020.12.006Search in Google Scholar PubMed
© 2022 Eva Tvrdá et al., published by De Gruyter
This work is licensed under the Creative Commons Attribution 4.0 International License.
Articles in the same Issue
- Biomedical Sciences
- Effects of direct oral anticoagulants dabigatran and rivaroxaban on the blood coagulation function in rabbits
- The mother of all battles: Viruses vs humans. Can humans avoid extinction in 50–100 years?
- Knockdown of G1P3 inhibits cell proliferation and enhances the cytotoxicity of dexamethasone in acute lymphoblastic leukemia
- LINC00665 regulates hepatocellular carcinoma by modulating mRNA via the m6A enzyme
- Association study of CLDN14 variations in patients with kidney stones
- Concanavalin A-induced autoimmune hepatitis model in mice: Mechanisms and future outlook
- Regulation of miR-30b in cancer development, apoptosis, and drug resistance
- Informatic analysis of the pulmonary microecology in non-cystic fibrosis bronchiectasis at three different stages
- Swimming attenuates tumor growth in CT-26 tumor-bearing mice and suppresses angiogenesis by mediating the HIF-1α/VEGFA pathway
- Characterization of intestinal microbiota and serum metabolites in patients with mild hepatic encephalopathy
- Functional conservation and divergence in plant-specific GRF gene family revealed by sequences and expression analysis
- Application of the FLP/LoxP-FRT recombination system to switch the eGFP expression in a model prokaryote
- Biomedical evaluation of antioxidant properties of lamb meat enriched with iodine and selenium
- Intravenous infusion of the exosomes derived from human umbilical cord mesenchymal stem cells enhance neurological recovery after traumatic brain injury via suppressing the NF-κB pathway
- Effect of dietary pattern on pregnant women with gestational diabetes mellitus and its clinical significance
- Potential regulatory mechanism of TNF-α/TNFR1/ANXA1 in glioma cells and its role in glioma cell proliferation
- Effect of the genetic mutant G71R in uridine diphosphate-glucuronosyltransferase 1A1 on the conjugation of bilirubin
- Quercetin inhibits cytotoxicity of PC12 cells induced by amyloid-beta 25–35 via stimulating estrogen receptor α, activating ERK1/2, and inhibiting apoptosis
- Nutrition intervention in the management of novel coronavirus pneumonia patients
- circ-CFH promotes the development of HCC by regulating cell proliferation, apoptosis, migration, invasion, and glycolysis through the miR-377-3p/RNF38 axis
- Bmi-1 directly upregulates glucose transporter 1 in human gastric adenocarcinoma
- Lacunar infarction aggravates the cognitive deficit in the elderly with white matter lesion
- Hydroxysafflor yellow A improved retinopathy via Nrf2/HO-1 pathway in rats
- Comparison of axon extension: PTFE versus PLA formed by a 3D printer
- Elevated IL-35 level and iTr35 subset increase the bacterial burden and lung lesions in Mycobacterium tuberculosis-infected mice
- A case report of CAT gene and HNF1β gene variations in a patient with early-onset diabetes
- Study on the mechanism of inhibiting patulin production by fengycin
- SOX4 promotes high-glucose-induced inflammation and angiogenesis of retinal endothelial cells by activating NF-κB signaling pathway
- Relationship between blood clots and COVID-19 vaccines: A literature review
- Analysis of genetic characteristics of 436 children with dysplasia and detailed analysis of rare karyotype
- Bioinformatics network analyses of growth differentiation factor 11
- NR4A1 inhibits the epithelial–mesenchymal transition of hepatic stellate cells: Involvement of TGF-β–Smad2/3/4–ZEB signaling
- Expression of Zeb1 in the differentiation of mouse embryonic stem cell
- Study on the genetic damage caused by cadmium sulfide quantum dots in human lymphocytes
- Association between single-nucleotide polymorphisms of NKX2.5 and congenital heart disease in Chinese population: A meta-analysis
- Assessment of the anesthetic effect of modified pentothal sodium solution on Sprague-Dawley rats
- Genetic susceptibility to high myopia in Han Chinese population
- Potential biomarkers and molecular mechanisms in preeclampsia progression
- Silencing circular RNA-friend leukemia virus integration 1 restrained malignancy of CC cells and oxaliplatin resistance by disturbing dyskeratosis congenita 1
- Endostar plus pembrolizumab combined with a platinum-based dual chemotherapy regime for advanced pulmonary large-cell neuroendocrine carcinoma as a first-line treatment: A case report
- The significance of PAK4 in signaling and clinicopathology: A review
- Sorafenib inhibits ovarian cancer cell proliferation and mobility and induces radiosensitivity by targeting the tumor cell epithelial–mesenchymal transition
- Characterization of rabbit polyclonal antibody against camel recombinant nanobodies
- Active legumain promotes invasion and migration of neuroblastoma by regulating epithelial-mesenchymal transition
- Effect of cell receptors in the pathogenesis of osteoarthritis: Current insights
- MT-12 inhibits the proliferation of bladder cells in vitro and in vivo by enhancing autophagy through mitochondrial dysfunction
- Study of hsa_circRNA_000121 and hsa_circRNA_004183 in papillary thyroid microcarcinoma
- BuyangHuanwu Decoction attenuates cerebral vasospasm caused by subarachnoid hemorrhage in rats via PI3K/AKT/eNOS axis
- Effects of the interaction of Notch and TLR4 pathways on inflammation and heart function in septic heart
- Monosodium iodoacetate-induced subchondral bone microstructure and inflammatory changes in an animal model of osteoarthritis
- A rare presentation of type II Abernethy malformation and nephrotic syndrome: Case report and review
- Rapid death due to pulmonary epithelioid haemangioendothelioma in several weeks: A case report
- Hepatoprotective role of peroxisome proliferator-activated receptor-α in non-cancerous hepatic tissues following transcatheter arterial embolization
- Correlation between peripheral blood lymphocyte subpopulations and primary systemic lupus erythematosus
- A novel SLC8A1-ALK fusion in lung adenocarcinoma confers sensitivity to alectinib: A case report
- β-Hydroxybutyrate upregulates FGF21 expression through inhibition of histone deacetylases in hepatocytes
- Identification of metabolic genes for the prediction of prognosis and tumor microenvironment infiltration in early-stage non-small cell lung cancer
- BTBD10 inhibits glioma tumorigenesis by downregulating cyclin D1 and p-Akt
- Mucormycosis co-infection in COVID-19 patients: An update
- Metagenomic next-generation sequencing in diagnosing Pneumocystis jirovecii pneumonia: A case report
- Long non-coding RNA HOXB-AS1 is a prognostic marker and promotes hepatocellular carcinoma cells’ proliferation and invasion
- Preparation and evaluation of LA-PEG-SPION, a targeted MRI contrast agent for liver cancer
- Proteomic analysis of the liver regulating lipid metabolism in Chaohu ducks using two-dimensional electrophoresis
- Nasopharyngeal tuberculosis: A case report
- Characterization and evaluation of anti-Salmonella enteritidis activity of indigenous probiotic lactobacilli in mice
- Aberrant pulmonary immune response of obese mice to periodontal infection
- Bacteriospermia – A formidable player in male subfertility
- In silico and in vivo analysis of TIPE1 expression in diffuse large B cell lymphoma
- Effects of KCa channels on biological behavior of trophoblasts
- Interleukin-17A influences the vulnerability rather than the size of established atherosclerotic plaques in apolipoprotein E-deficient mice
- Multiple organ failure and death caused by Staphylococcus aureus hip infection: A case report
- Prognostic signature related to the immune environment of oral squamous cell carcinoma
- Primary and metastatic squamous cell carcinoma of the thyroid gland: Two case reports
- Neuroprotective effects of crocin and crocin-loaded niosomes against the paraquat-induced oxidative brain damage in rats
- Role of MMP-2 and CD147 in kidney fibrosis
- Geometric basis of action potential of skeletal muscle cells and neurons
- Babesia microti-induced fulminant sepsis in an immunocompromised host: A case report and the case-specific literature review
- Role of cerebellar cortex in associative learning and memory in guinea pigs
- Application of metagenomic next-generation sequencing technique for diagnosing a specific case of necrotizing meningoencephalitis caused by human herpesvirus 2
- Case report: Quadruple primary malignant neoplasms including esophageal, ureteral, and lung in an elderly male
- Long non-coding RNA NEAT1 promotes angiogenesis in hepatoma carcinoma via the miR-125a-5p/VEGF pathway
- Osteogenic differentiation of periodontal membrane stem cells in inflammatory environments
- Knockdown of SHMT2 enhances the sensitivity of gastric cancer cells to radiotherapy through the Wnt/β-catenin pathway
- Continuous renal replacement therapy combined with double filtration plasmapheresis in the treatment of severe lupus complicated by serious bacterial infections in children: A case report
- Simultaneous triple primary malignancies, including bladder cancer, lymphoma, and lung cancer, in an elderly male: A case report
- Preclinical immunogenicity assessment of a cell-based inactivated whole-virion H5N1 influenza vaccine
- One case of iodine-125 therapy – A new minimally invasive treatment of intrahepatic cholangiocarcinoma
- S1P promotes corneal trigeminal neuron differentiation and corneal nerve repair via upregulating nerve growth factor expression in a mouse model
- Early cancer detection by a targeted methylation assay of circulating tumor DNA in plasma
- Calcifying nanoparticles initiate the calcification process of mesenchymal stem cells in vitro through the activation of the TGF-β1/Smad signaling pathway and promote the decay of echinococcosis
- Evaluation of prognostic markers in patients infected with SARS-CoV-2
- N6-Methyladenosine-related alternative splicing events play a role in bladder cancer
- Characterization of the structural, oxidative, and immunological features of testis tissue from Zucker diabetic fatty rats
- Effects of glucose and osmotic pressure on the proliferation and cell cycle of human chorionic trophoblast cells
- Investigation of genotype diversity of 7,804 norovirus sequences in humans and animals of China
- Characteristics and karyotype analysis of a patient with turner syndrome complicated with multiple-site tumors: A case report
- Aggravated renal fibrosis is positively associated with the activation of HMGB1-TLR2/4 signaling in STZ-induced diabetic mice
- Distribution characteristics of SARS-CoV-2 IgM/IgG in false-positive results detected by chemiluminescent immunoassay
- SRPX2 attenuated oxygen–glucose deprivation and reperfusion-induced injury in cardiomyocytes via alleviating endoplasmic reticulum stress-induced apoptosis through targeting PI3K/Akt/mTOR axis
- Aquaporin-8 overexpression is involved in vascular structure and function changes in placentas of gestational diabetes mellitus patients
- Relationship between CRP gene polymorphisms and ischemic stroke risk: A systematic review and meta-analysis
- Effects of growth hormone on lipid metabolism and sexual development in pubertal obese male rats
- Cloning and identification of the CTLA-4IgV gene and functional application of vaccine in Xinjiang sheep
- Antitumor activity of RUNX3: Upregulation of E-cadherin and downregulation of the epithelial–mesenchymal transition in clear-cell renal cell carcinoma
- PHF8 promotes osteogenic differentiation of BMSCs in old rat with osteoporosis by regulating Wnt/β-catenin pathway
- A review of the current state of the computer-aided diagnosis (CAD) systems for breast cancer diagnosis
- Bilateral dacryoadenitis in adult-onset Still’s disease: A case report
- A novel association between Bmi-1 protein expression and the SUVmax obtained by 18F-FDG PET/CT in patients with gastric adenocarcinoma
- The role of erythrocytes and erythroid progenitor cells in tumors
- Relationship between platelet activation markers and spontaneous abortion: A meta-analysis
- Abnormal methylation caused by folic acid deficiency in neural tube defects
- Silencing TLR4 using an ultrasound-targeted microbubble destruction-based shRNA system reduces ischemia-induced seizures in hyperglycemic rats
- Plant Sciences
- Seasonal succession of bacterial communities in cultured Caulerpa lentillifera detected by high-throughput sequencing
- Cloning and prokaryotic expression of WRKY48 from Caragana intermedia
- Novel Brassica hybrids with different resistance to Leptosphaeria maculans reveal unbalanced rDNA signal patterns
- Application of exogenous auxin and gibberellin regulates the bolting of lettuce (Lactuca sativa L.)
- Phytoremediation of pollutants from wastewater: A concise review
- Genome-wide identification and characterization of NBS-encoding genes in the sweet potato wild ancestor Ipomoea trifida (H.B.K.)
- Alleviative effects of magnetic Fe3O4 nanoparticles on the physiological toxicity of 3-nitrophenol to rice (Oryza sativa L.) seedlings
- Selection and functional identification of Dof genes expressed in response to nitrogen in Populus simonii × Populus nigra
- Study on pecan seed germination influenced by seed endocarp
- Identification of active compounds in Ophiopogonis Radix from different geographical origins by UPLC-Q/TOF-MS combined with GC-MS approaches
- The entire chloroplast genome sequence of Asparagus cochinchinensis and genetic comparison to Asparagus species
- Genome-wide identification of MAPK family genes and their response to abiotic stresses in tea plant (Camellia sinensis)
- Selection and validation of reference genes for RT-qPCR analysis of different organs at various development stages in Caragana intermedia
- Cloning and expression analysis of SERK1 gene in Diospyros lotus
- Integrated metabolomic and transcriptomic profiling revealed coping mechanisms of the edible and medicinal homologous plant Plantago asiatica L. cadmium resistance
- A missense variant in NCF1 is associated with susceptibility to unexplained recurrent spontaneous abortion
- Assessment of drought tolerance indices in faba bean genotypes under different irrigation regimes
- The entire chloroplast genome sequence of Asparagus setaceus (Kunth) Jessop: Genome structure, gene composition, and phylogenetic analysis in Asparagaceae
- Food Science
- Dietary food additive monosodium glutamate with or without high-lipid diet induces spleen anomaly: A mechanistic approach on rat model
- Binge eating disorder during COVID-19
- Potential of honey against the onset of autoimmune diabetes and its associated nephropathy, pancreatitis, and retinopathy in type 1 diabetic animal model
- FTO gene expression in diet-induced obesity is downregulated by Solanum fruit supplementation
- Physical activity enhances fecal lactobacilli in rats chronically drinking sweetened cola beverage
- Supercritical CO2 extraction, chemical composition, and antioxidant effects of Coreopsis tinctoria Nutt. oleoresin
- Functional constituents of plant-based foods boost immunity against acute and chronic disorders
- Effect of selenium and methods of protein extraction on the proteomic profile of Saccharomyces yeast
- Microbial diversity of milk ghee in southern Gansu and its effect on the formation of ghee flavor compounds
- Ecology and Environmental Sciences
- Effects of heavy metals on bacterial community surrounding Bijiashan mining area located in northwest China
- Microorganism community composition analysis coupling with 15N tracer experiments reveals the nitrification rate and N2O emissions in low pH soils in Southern China
- Genetic diversity and population structure of Cinnamomum balansae Lecomte inferred by microsatellites
- Preliminary screening of microplastic contamination in different marine fish species of Taif market, Saudi Arabia
- Plant volatile organic compounds attractive to Lygus pratensis
- Effects of organic materials on soil bacterial community structure in long-term continuous cropping of tomato in greenhouse
- Effects of soil treated fungicide fluopimomide on tomato (Solanum lycopersicum L.) disease control and plant growth
- Prevalence of Yersinia pestis among rodents captured in a semi-arid tropical ecosystem of south-western Zimbabwe
- Effects of irrigation and nitrogen fertilization on mitigating salt-induced Na+ toxicity and sustaining sea rice growth
- Bioengineering and Biotechnology
- Poly-l-lysine-caused cell adhesion induces pyroptosis in THP-1 monocytes
- Development of alkaline phosphatase-scFv and its use for one-step enzyme-linked immunosorbent assay for His-tagged protein detection
- Development and validation of a predictive model for immune-related genes in patients with tongue squamous cell carcinoma
- Agriculture
- Effects of chemical-based fertilizer replacement with biochar-based fertilizer on albic soil nutrient content and maize yield
- Genome-wide identification and expression analysis of CPP-like gene family in Triticum aestivum L. under different hormone and stress conditions
- Agronomic and economic performance of mung bean (Vigna radiata L.) varieties in response to rates of blended NPS fertilizer in Kindo Koysha district, Southern Ethiopia
- Influence of furrow irrigation regime on the yield and water consumption indicators of winter wheat based on a multi-level fuzzy comprehensive evaluation
- Discovery of exercise-related genes and pathway analysis based on comparative genomes of Mongolian originated Abaga and Wushen horse
- Lessons from integrated seasonal forecast-crop modelling in Africa: A systematic review
- Evolution trend of soil fertility in tobacco-planting area of Chenzhou, Hunan Province, China
- Animal Sciences
- Morphological and molecular characterization of Tatera indica Hardwicke 1807 (Rodentia: Muridae) from Pothwar, Pakistan
- Research on meat quality of Qianhua Mutton Merino sheep and Small-tail Han sheep
- SI: A Scientific Memoir
- Suggestions on leading an academic research laboratory group
- My scientific genealogy and the Toronto ACDC Laboratory, 1988–2022
- Erratum
- Erratum to “Changes of immune cells in patients with hepatocellular carcinoma treated by radiofrequency ablation and hepatectomy, a pilot study”
- Erratum to “A two-microRNA signature predicts the progression of male thyroid cancer”
- Retraction
- Retraction of “Lidocaine has antitumor effect on hepatocellular carcinoma via the circ_DYNC1H1/miR-520a-3p/USP14 axis”
Articles in the same Issue
- Biomedical Sciences
- Effects of direct oral anticoagulants dabigatran and rivaroxaban on the blood coagulation function in rabbits
- The mother of all battles: Viruses vs humans. Can humans avoid extinction in 50–100 years?
- Knockdown of G1P3 inhibits cell proliferation and enhances the cytotoxicity of dexamethasone in acute lymphoblastic leukemia
- LINC00665 regulates hepatocellular carcinoma by modulating mRNA via the m6A enzyme
- Association study of CLDN14 variations in patients with kidney stones
- Concanavalin A-induced autoimmune hepatitis model in mice: Mechanisms and future outlook
- Regulation of miR-30b in cancer development, apoptosis, and drug resistance
- Informatic analysis of the pulmonary microecology in non-cystic fibrosis bronchiectasis at three different stages
- Swimming attenuates tumor growth in CT-26 tumor-bearing mice and suppresses angiogenesis by mediating the HIF-1α/VEGFA pathway
- Characterization of intestinal microbiota and serum metabolites in patients with mild hepatic encephalopathy
- Functional conservation and divergence in plant-specific GRF gene family revealed by sequences and expression analysis
- Application of the FLP/LoxP-FRT recombination system to switch the eGFP expression in a model prokaryote
- Biomedical evaluation of antioxidant properties of lamb meat enriched with iodine and selenium
- Intravenous infusion of the exosomes derived from human umbilical cord mesenchymal stem cells enhance neurological recovery after traumatic brain injury via suppressing the NF-κB pathway
- Effect of dietary pattern on pregnant women with gestational diabetes mellitus and its clinical significance
- Potential regulatory mechanism of TNF-α/TNFR1/ANXA1 in glioma cells and its role in glioma cell proliferation
- Effect of the genetic mutant G71R in uridine diphosphate-glucuronosyltransferase 1A1 on the conjugation of bilirubin
- Quercetin inhibits cytotoxicity of PC12 cells induced by amyloid-beta 25–35 via stimulating estrogen receptor α, activating ERK1/2, and inhibiting apoptosis
- Nutrition intervention in the management of novel coronavirus pneumonia patients
- circ-CFH promotes the development of HCC by regulating cell proliferation, apoptosis, migration, invasion, and glycolysis through the miR-377-3p/RNF38 axis
- Bmi-1 directly upregulates glucose transporter 1 in human gastric adenocarcinoma
- Lacunar infarction aggravates the cognitive deficit in the elderly with white matter lesion
- Hydroxysafflor yellow A improved retinopathy via Nrf2/HO-1 pathway in rats
- Comparison of axon extension: PTFE versus PLA formed by a 3D printer
- Elevated IL-35 level and iTr35 subset increase the bacterial burden and lung lesions in Mycobacterium tuberculosis-infected mice
- A case report of CAT gene and HNF1β gene variations in a patient with early-onset diabetes
- Study on the mechanism of inhibiting patulin production by fengycin
- SOX4 promotes high-glucose-induced inflammation and angiogenesis of retinal endothelial cells by activating NF-κB signaling pathway
- Relationship between blood clots and COVID-19 vaccines: A literature review
- Analysis of genetic characteristics of 436 children with dysplasia and detailed analysis of rare karyotype
- Bioinformatics network analyses of growth differentiation factor 11
- NR4A1 inhibits the epithelial–mesenchymal transition of hepatic stellate cells: Involvement of TGF-β–Smad2/3/4–ZEB signaling
- Expression of Zeb1 in the differentiation of mouse embryonic stem cell
- Study on the genetic damage caused by cadmium sulfide quantum dots in human lymphocytes
- Association between single-nucleotide polymorphisms of NKX2.5 and congenital heart disease in Chinese population: A meta-analysis
- Assessment of the anesthetic effect of modified pentothal sodium solution on Sprague-Dawley rats
- Genetic susceptibility to high myopia in Han Chinese population
- Potential biomarkers and molecular mechanisms in preeclampsia progression
- Silencing circular RNA-friend leukemia virus integration 1 restrained malignancy of CC cells and oxaliplatin resistance by disturbing dyskeratosis congenita 1
- Endostar plus pembrolizumab combined with a platinum-based dual chemotherapy regime for advanced pulmonary large-cell neuroendocrine carcinoma as a first-line treatment: A case report
- The significance of PAK4 in signaling and clinicopathology: A review
- Sorafenib inhibits ovarian cancer cell proliferation and mobility and induces radiosensitivity by targeting the tumor cell epithelial–mesenchymal transition
- Characterization of rabbit polyclonal antibody against camel recombinant nanobodies
- Active legumain promotes invasion and migration of neuroblastoma by regulating epithelial-mesenchymal transition
- Effect of cell receptors in the pathogenesis of osteoarthritis: Current insights
- MT-12 inhibits the proliferation of bladder cells in vitro and in vivo by enhancing autophagy through mitochondrial dysfunction
- Study of hsa_circRNA_000121 and hsa_circRNA_004183 in papillary thyroid microcarcinoma
- BuyangHuanwu Decoction attenuates cerebral vasospasm caused by subarachnoid hemorrhage in rats via PI3K/AKT/eNOS axis
- Effects of the interaction of Notch and TLR4 pathways on inflammation and heart function in septic heart
- Monosodium iodoacetate-induced subchondral bone microstructure and inflammatory changes in an animal model of osteoarthritis
- A rare presentation of type II Abernethy malformation and nephrotic syndrome: Case report and review
- Rapid death due to pulmonary epithelioid haemangioendothelioma in several weeks: A case report
- Hepatoprotective role of peroxisome proliferator-activated receptor-α in non-cancerous hepatic tissues following transcatheter arterial embolization
- Correlation between peripheral blood lymphocyte subpopulations and primary systemic lupus erythematosus
- A novel SLC8A1-ALK fusion in lung adenocarcinoma confers sensitivity to alectinib: A case report
- β-Hydroxybutyrate upregulates FGF21 expression through inhibition of histone deacetylases in hepatocytes
- Identification of metabolic genes for the prediction of prognosis and tumor microenvironment infiltration in early-stage non-small cell lung cancer
- BTBD10 inhibits glioma tumorigenesis by downregulating cyclin D1 and p-Akt
- Mucormycosis co-infection in COVID-19 patients: An update
- Metagenomic next-generation sequencing in diagnosing Pneumocystis jirovecii pneumonia: A case report
- Long non-coding RNA HOXB-AS1 is a prognostic marker and promotes hepatocellular carcinoma cells’ proliferation and invasion
- Preparation and evaluation of LA-PEG-SPION, a targeted MRI contrast agent for liver cancer
- Proteomic analysis of the liver regulating lipid metabolism in Chaohu ducks using two-dimensional electrophoresis
- Nasopharyngeal tuberculosis: A case report
- Characterization and evaluation of anti-Salmonella enteritidis activity of indigenous probiotic lactobacilli in mice
- Aberrant pulmonary immune response of obese mice to periodontal infection
- Bacteriospermia – A formidable player in male subfertility
- In silico and in vivo analysis of TIPE1 expression in diffuse large B cell lymphoma
- Effects of KCa channels on biological behavior of trophoblasts
- Interleukin-17A influences the vulnerability rather than the size of established atherosclerotic plaques in apolipoprotein E-deficient mice
- Multiple organ failure and death caused by Staphylococcus aureus hip infection: A case report
- Prognostic signature related to the immune environment of oral squamous cell carcinoma
- Primary and metastatic squamous cell carcinoma of the thyroid gland: Two case reports
- Neuroprotective effects of crocin and crocin-loaded niosomes against the paraquat-induced oxidative brain damage in rats
- Role of MMP-2 and CD147 in kidney fibrosis
- Geometric basis of action potential of skeletal muscle cells and neurons
- Babesia microti-induced fulminant sepsis in an immunocompromised host: A case report and the case-specific literature review
- Role of cerebellar cortex in associative learning and memory in guinea pigs
- Application of metagenomic next-generation sequencing technique for diagnosing a specific case of necrotizing meningoencephalitis caused by human herpesvirus 2
- Case report: Quadruple primary malignant neoplasms including esophageal, ureteral, and lung in an elderly male
- Long non-coding RNA NEAT1 promotes angiogenesis in hepatoma carcinoma via the miR-125a-5p/VEGF pathway
- Osteogenic differentiation of periodontal membrane stem cells in inflammatory environments
- Knockdown of SHMT2 enhances the sensitivity of gastric cancer cells to radiotherapy through the Wnt/β-catenin pathway
- Continuous renal replacement therapy combined with double filtration plasmapheresis in the treatment of severe lupus complicated by serious bacterial infections in children: A case report
- Simultaneous triple primary malignancies, including bladder cancer, lymphoma, and lung cancer, in an elderly male: A case report
- Preclinical immunogenicity assessment of a cell-based inactivated whole-virion H5N1 influenza vaccine
- One case of iodine-125 therapy – A new minimally invasive treatment of intrahepatic cholangiocarcinoma
- S1P promotes corneal trigeminal neuron differentiation and corneal nerve repair via upregulating nerve growth factor expression in a mouse model
- Early cancer detection by a targeted methylation assay of circulating tumor DNA in plasma
- Calcifying nanoparticles initiate the calcification process of mesenchymal stem cells in vitro through the activation of the TGF-β1/Smad signaling pathway and promote the decay of echinococcosis
- Evaluation of prognostic markers in patients infected with SARS-CoV-2
- N6-Methyladenosine-related alternative splicing events play a role in bladder cancer
- Characterization of the structural, oxidative, and immunological features of testis tissue from Zucker diabetic fatty rats
- Effects of glucose and osmotic pressure on the proliferation and cell cycle of human chorionic trophoblast cells
- Investigation of genotype diversity of 7,804 norovirus sequences in humans and animals of China
- Characteristics and karyotype analysis of a patient with turner syndrome complicated with multiple-site tumors: A case report
- Aggravated renal fibrosis is positively associated with the activation of HMGB1-TLR2/4 signaling in STZ-induced diabetic mice
- Distribution characteristics of SARS-CoV-2 IgM/IgG in false-positive results detected by chemiluminescent immunoassay
- SRPX2 attenuated oxygen–glucose deprivation and reperfusion-induced injury in cardiomyocytes via alleviating endoplasmic reticulum stress-induced apoptosis through targeting PI3K/Akt/mTOR axis
- Aquaporin-8 overexpression is involved in vascular structure and function changes in placentas of gestational diabetes mellitus patients
- Relationship between CRP gene polymorphisms and ischemic stroke risk: A systematic review and meta-analysis
- Effects of growth hormone on lipid metabolism and sexual development in pubertal obese male rats
- Cloning and identification of the CTLA-4IgV gene and functional application of vaccine in Xinjiang sheep
- Antitumor activity of RUNX3: Upregulation of E-cadherin and downregulation of the epithelial–mesenchymal transition in clear-cell renal cell carcinoma
- PHF8 promotes osteogenic differentiation of BMSCs in old rat with osteoporosis by regulating Wnt/β-catenin pathway
- A review of the current state of the computer-aided diagnosis (CAD) systems for breast cancer diagnosis
- Bilateral dacryoadenitis in adult-onset Still’s disease: A case report
- A novel association between Bmi-1 protein expression and the SUVmax obtained by 18F-FDG PET/CT in patients with gastric adenocarcinoma
- The role of erythrocytes and erythroid progenitor cells in tumors
- Relationship between platelet activation markers and spontaneous abortion: A meta-analysis
- Abnormal methylation caused by folic acid deficiency in neural tube defects
- Silencing TLR4 using an ultrasound-targeted microbubble destruction-based shRNA system reduces ischemia-induced seizures in hyperglycemic rats
- Plant Sciences
- Seasonal succession of bacterial communities in cultured Caulerpa lentillifera detected by high-throughput sequencing
- Cloning and prokaryotic expression of WRKY48 from Caragana intermedia
- Novel Brassica hybrids with different resistance to Leptosphaeria maculans reveal unbalanced rDNA signal patterns
- Application of exogenous auxin and gibberellin regulates the bolting of lettuce (Lactuca sativa L.)
- Phytoremediation of pollutants from wastewater: A concise review
- Genome-wide identification and characterization of NBS-encoding genes in the sweet potato wild ancestor Ipomoea trifida (H.B.K.)
- Alleviative effects of magnetic Fe3O4 nanoparticles on the physiological toxicity of 3-nitrophenol to rice (Oryza sativa L.) seedlings
- Selection and functional identification of Dof genes expressed in response to nitrogen in Populus simonii × Populus nigra
- Study on pecan seed germination influenced by seed endocarp
- Identification of active compounds in Ophiopogonis Radix from different geographical origins by UPLC-Q/TOF-MS combined with GC-MS approaches
- The entire chloroplast genome sequence of Asparagus cochinchinensis and genetic comparison to Asparagus species
- Genome-wide identification of MAPK family genes and their response to abiotic stresses in tea plant (Camellia sinensis)
- Selection and validation of reference genes for RT-qPCR analysis of different organs at various development stages in Caragana intermedia
- Cloning and expression analysis of SERK1 gene in Diospyros lotus
- Integrated metabolomic and transcriptomic profiling revealed coping mechanisms of the edible and medicinal homologous plant Plantago asiatica L. cadmium resistance
- A missense variant in NCF1 is associated with susceptibility to unexplained recurrent spontaneous abortion
- Assessment of drought tolerance indices in faba bean genotypes under different irrigation regimes
- The entire chloroplast genome sequence of Asparagus setaceus (Kunth) Jessop: Genome structure, gene composition, and phylogenetic analysis in Asparagaceae
- Food Science
- Dietary food additive monosodium glutamate with or without high-lipid diet induces spleen anomaly: A mechanistic approach on rat model
- Binge eating disorder during COVID-19
- Potential of honey against the onset of autoimmune diabetes and its associated nephropathy, pancreatitis, and retinopathy in type 1 diabetic animal model
- FTO gene expression in diet-induced obesity is downregulated by Solanum fruit supplementation
- Physical activity enhances fecal lactobacilli in rats chronically drinking sweetened cola beverage
- Supercritical CO2 extraction, chemical composition, and antioxidant effects of Coreopsis tinctoria Nutt. oleoresin
- Functional constituents of plant-based foods boost immunity against acute and chronic disorders
- Effect of selenium and methods of protein extraction on the proteomic profile of Saccharomyces yeast
- Microbial diversity of milk ghee in southern Gansu and its effect on the formation of ghee flavor compounds
- Ecology and Environmental Sciences
- Effects of heavy metals on bacterial community surrounding Bijiashan mining area located in northwest China
- Microorganism community composition analysis coupling with 15N tracer experiments reveals the nitrification rate and N2O emissions in low pH soils in Southern China
- Genetic diversity and population structure of Cinnamomum balansae Lecomte inferred by microsatellites
- Preliminary screening of microplastic contamination in different marine fish species of Taif market, Saudi Arabia
- Plant volatile organic compounds attractive to Lygus pratensis
- Effects of organic materials on soil bacterial community structure in long-term continuous cropping of tomato in greenhouse
- Effects of soil treated fungicide fluopimomide on tomato (Solanum lycopersicum L.) disease control and plant growth
- Prevalence of Yersinia pestis among rodents captured in a semi-arid tropical ecosystem of south-western Zimbabwe
- Effects of irrigation and nitrogen fertilization on mitigating salt-induced Na+ toxicity and sustaining sea rice growth
- Bioengineering and Biotechnology
- Poly-l-lysine-caused cell adhesion induces pyroptosis in THP-1 monocytes
- Development of alkaline phosphatase-scFv and its use for one-step enzyme-linked immunosorbent assay for His-tagged protein detection
- Development and validation of a predictive model for immune-related genes in patients with tongue squamous cell carcinoma
- Agriculture
- Effects of chemical-based fertilizer replacement with biochar-based fertilizer on albic soil nutrient content and maize yield
- Genome-wide identification and expression analysis of CPP-like gene family in Triticum aestivum L. under different hormone and stress conditions
- Agronomic and economic performance of mung bean (Vigna radiata L.) varieties in response to rates of blended NPS fertilizer in Kindo Koysha district, Southern Ethiopia
- Influence of furrow irrigation regime on the yield and water consumption indicators of winter wheat based on a multi-level fuzzy comprehensive evaluation
- Discovery of exercise-related genes and pathway analysis based on comparative genomes of Mongolian originated Abaga and Wushen horse
- Lessons from integrated seasonal forecast-crop modelling in Africa: A systematic review
- Evolution trend of soil fertility in tobacco-planting area of Chenzhou, Hunan Province, China
- Animal Sciences
- Morphological and molecular characterization of Tatera indica Hardwicke 1807 (Rodentia: Muridae) from Pothwar, Pakistan
- Research on meat quality of Qianhua Mutton Merino sheep and Small-tail Han sheep
- SI: A Scientific Memoir
- Suggestions on leading an academic research laboratory group
- My scientific genealogy and the Toronto ACDC Laboratory, 1988–2022
- Erratum
- Erratum to “Changes of immune cells in patients with hepatocellular carcinoma treated by radiofrequency ablation and hepatectomy, a pilot study”
- Erratum to “A two-microRNA signature predicts the progression of male thyroid cancer”
- Retraction
- Retraction of “Lidocaine has antitumor effect on hepatocellular carcinoma via the circ_DYNC1H1/miR-520a-3p/USP14 axis”

